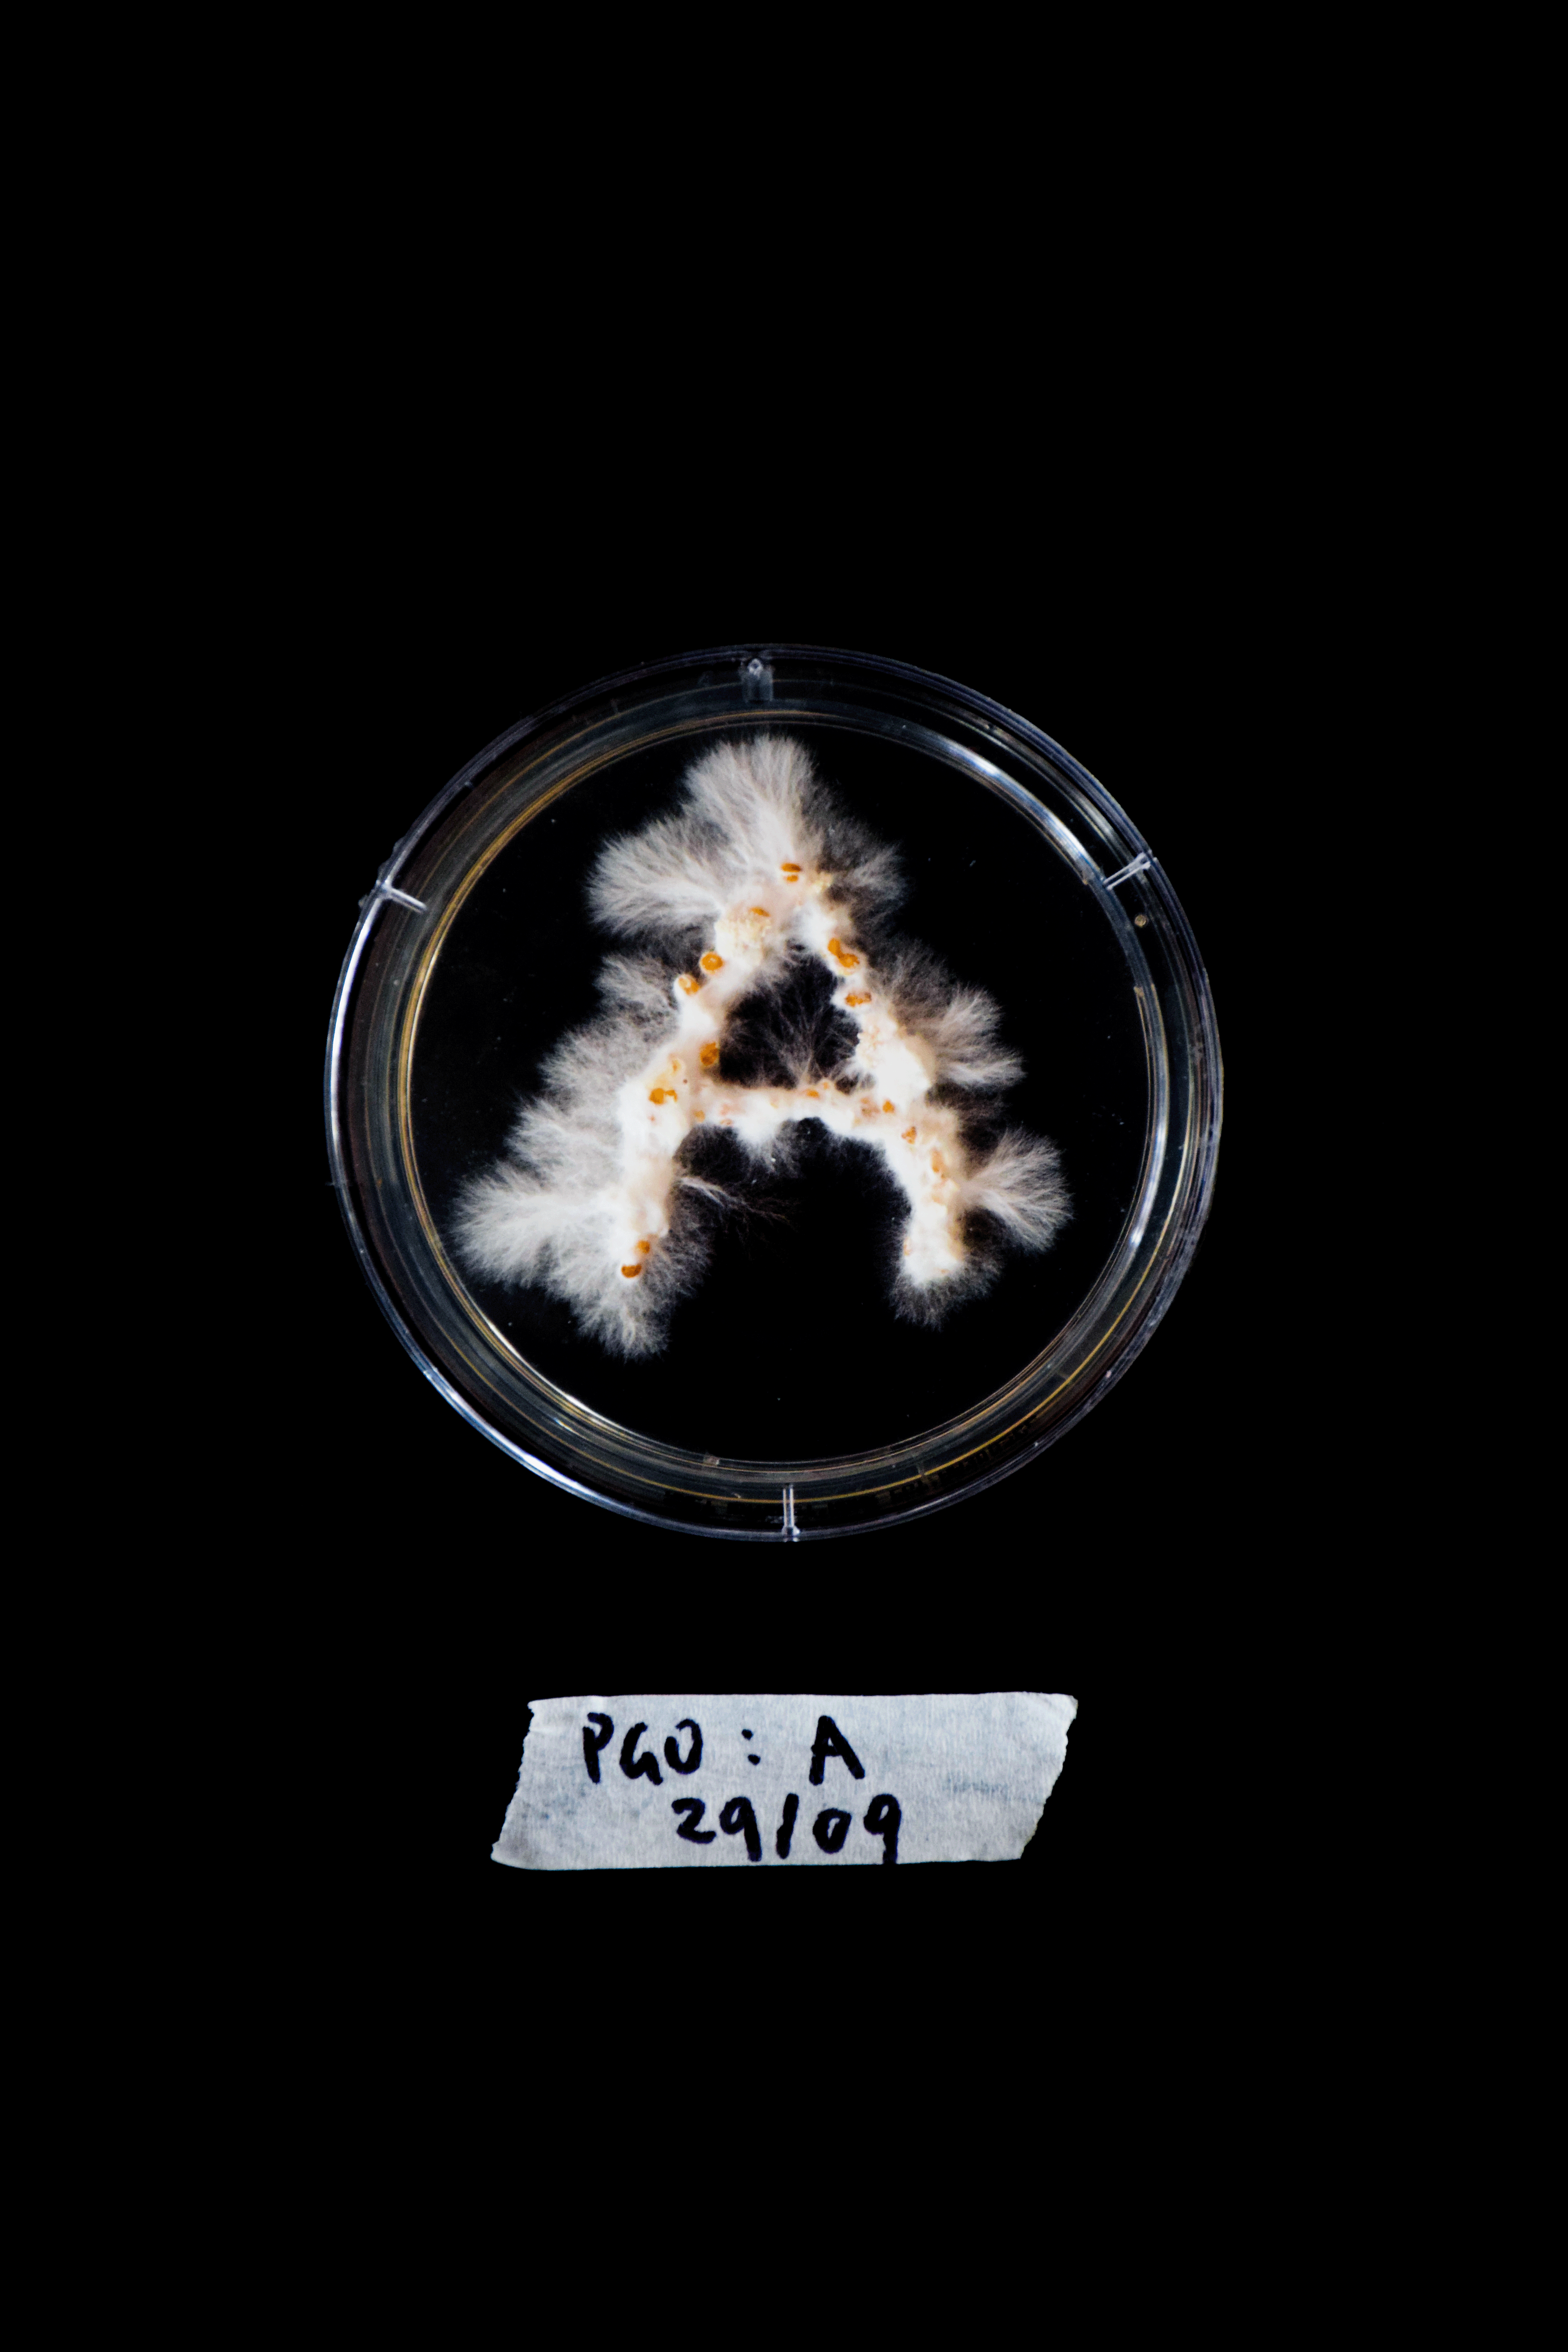
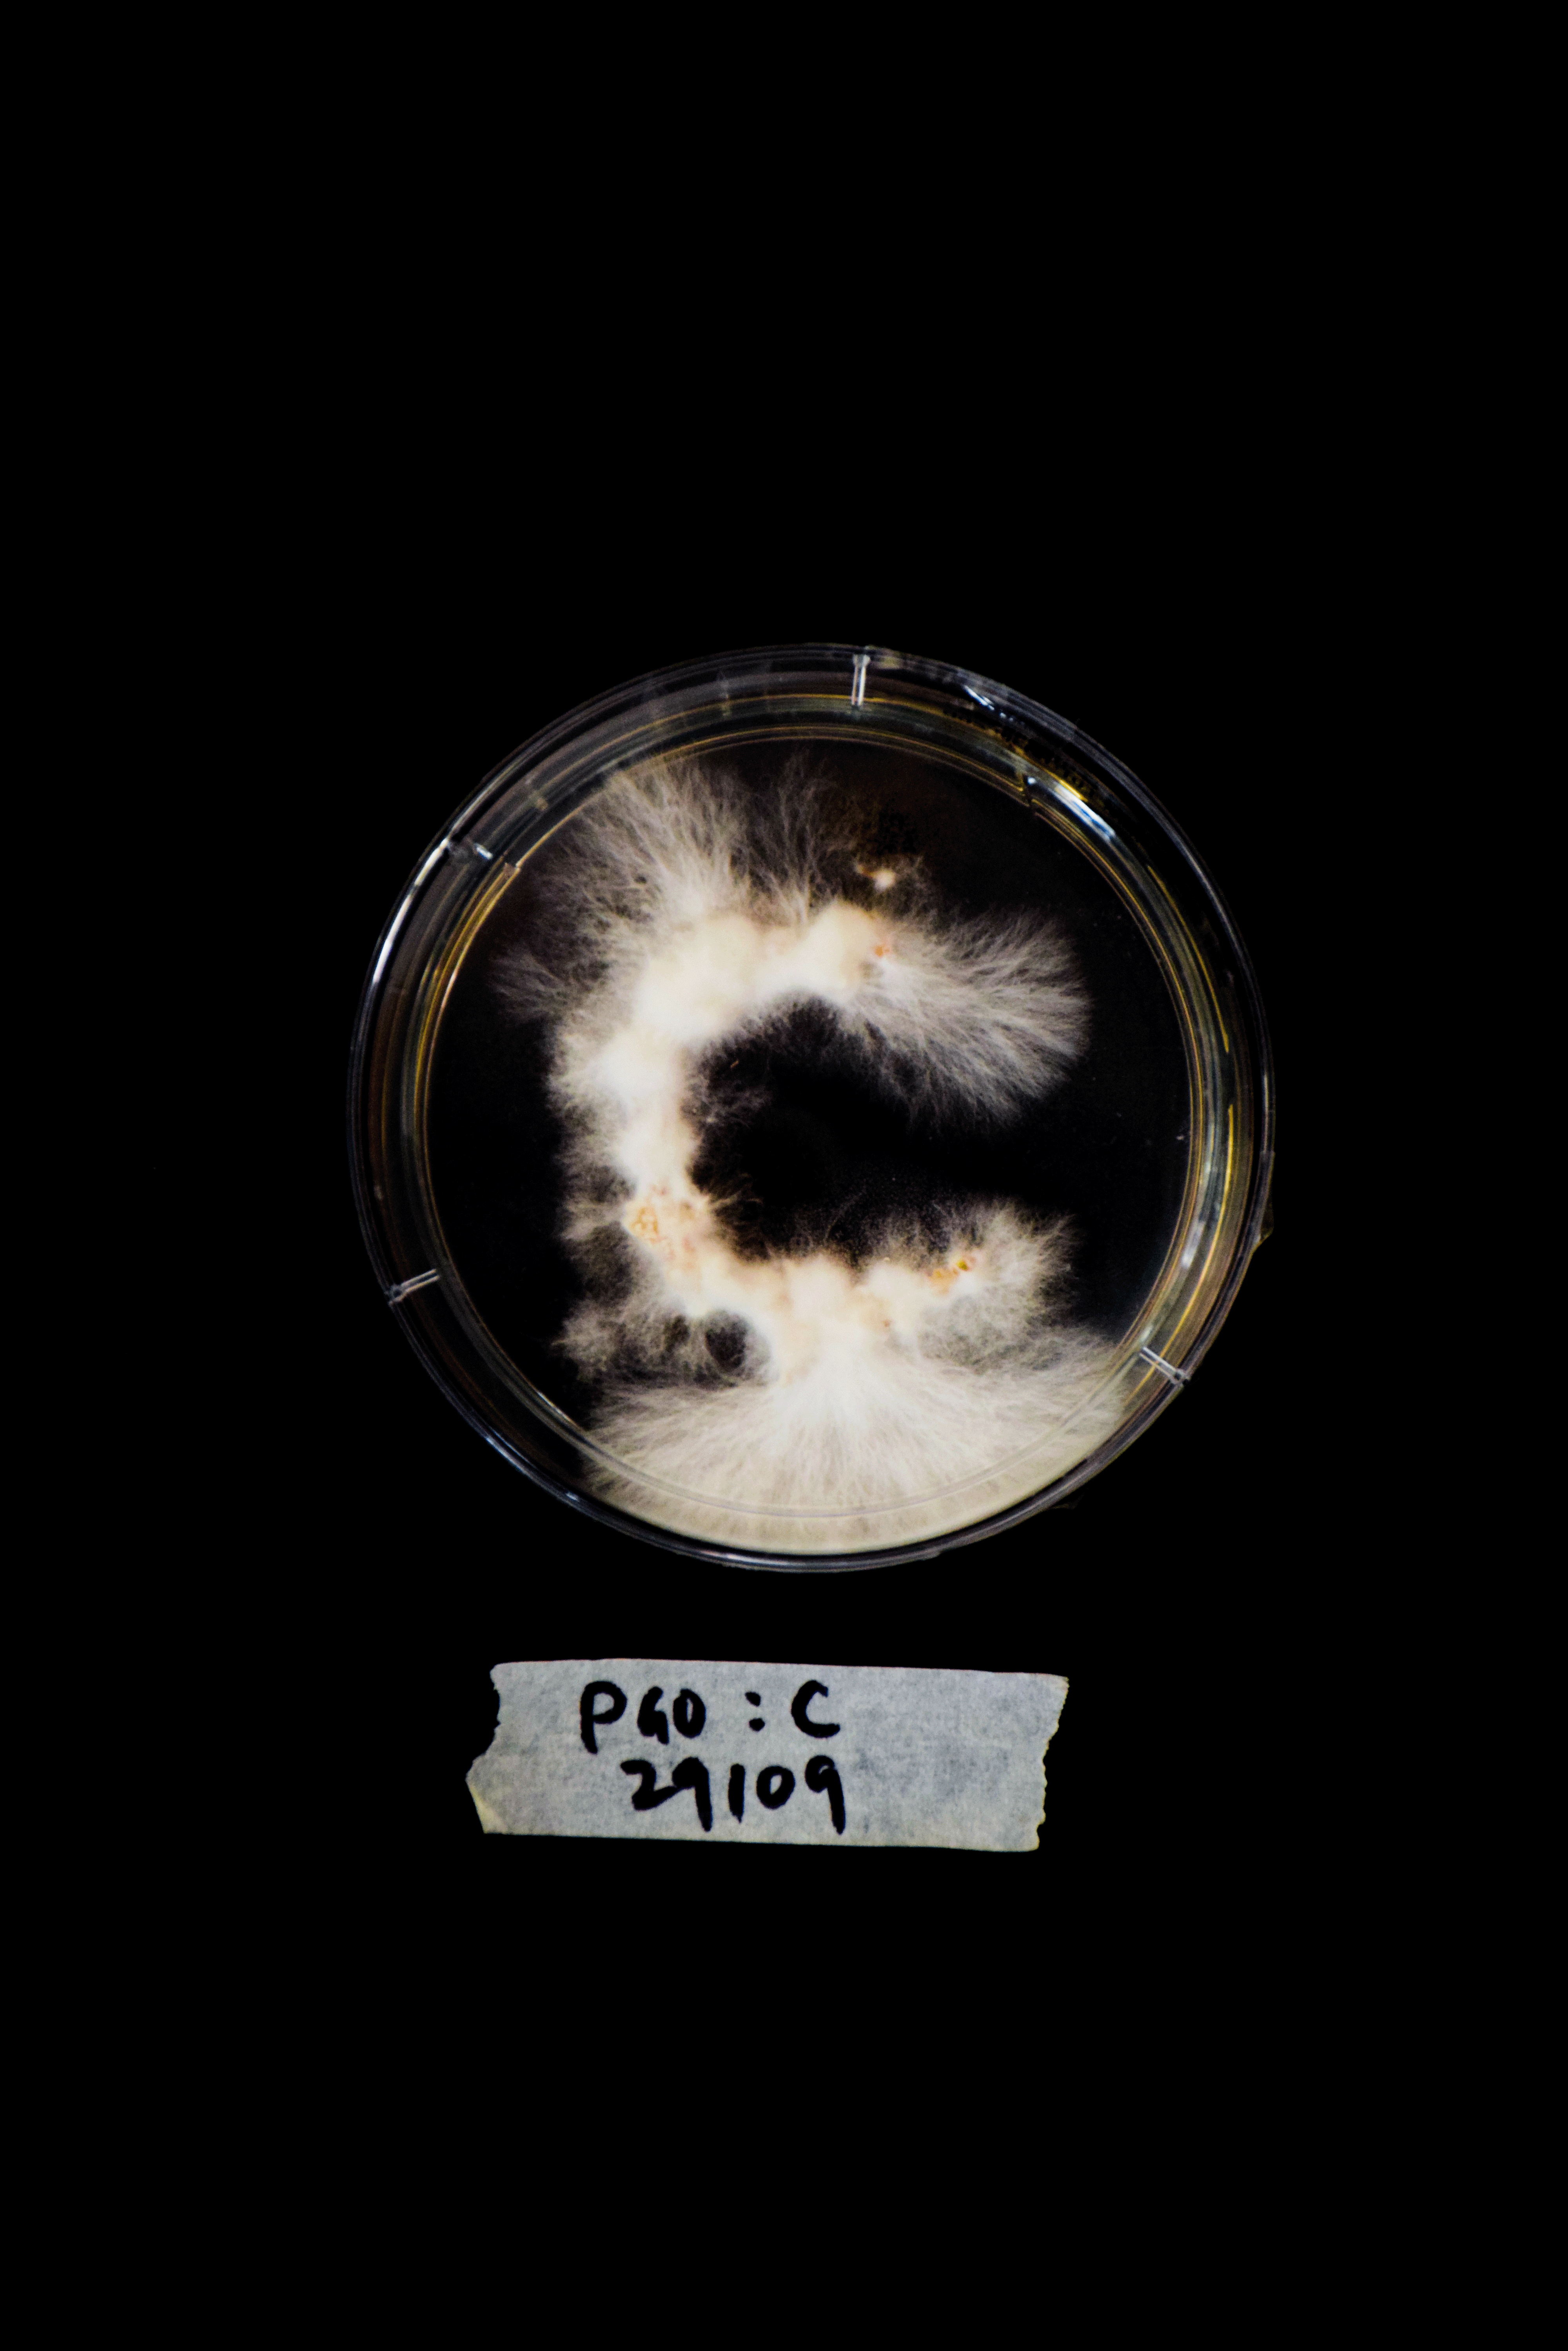
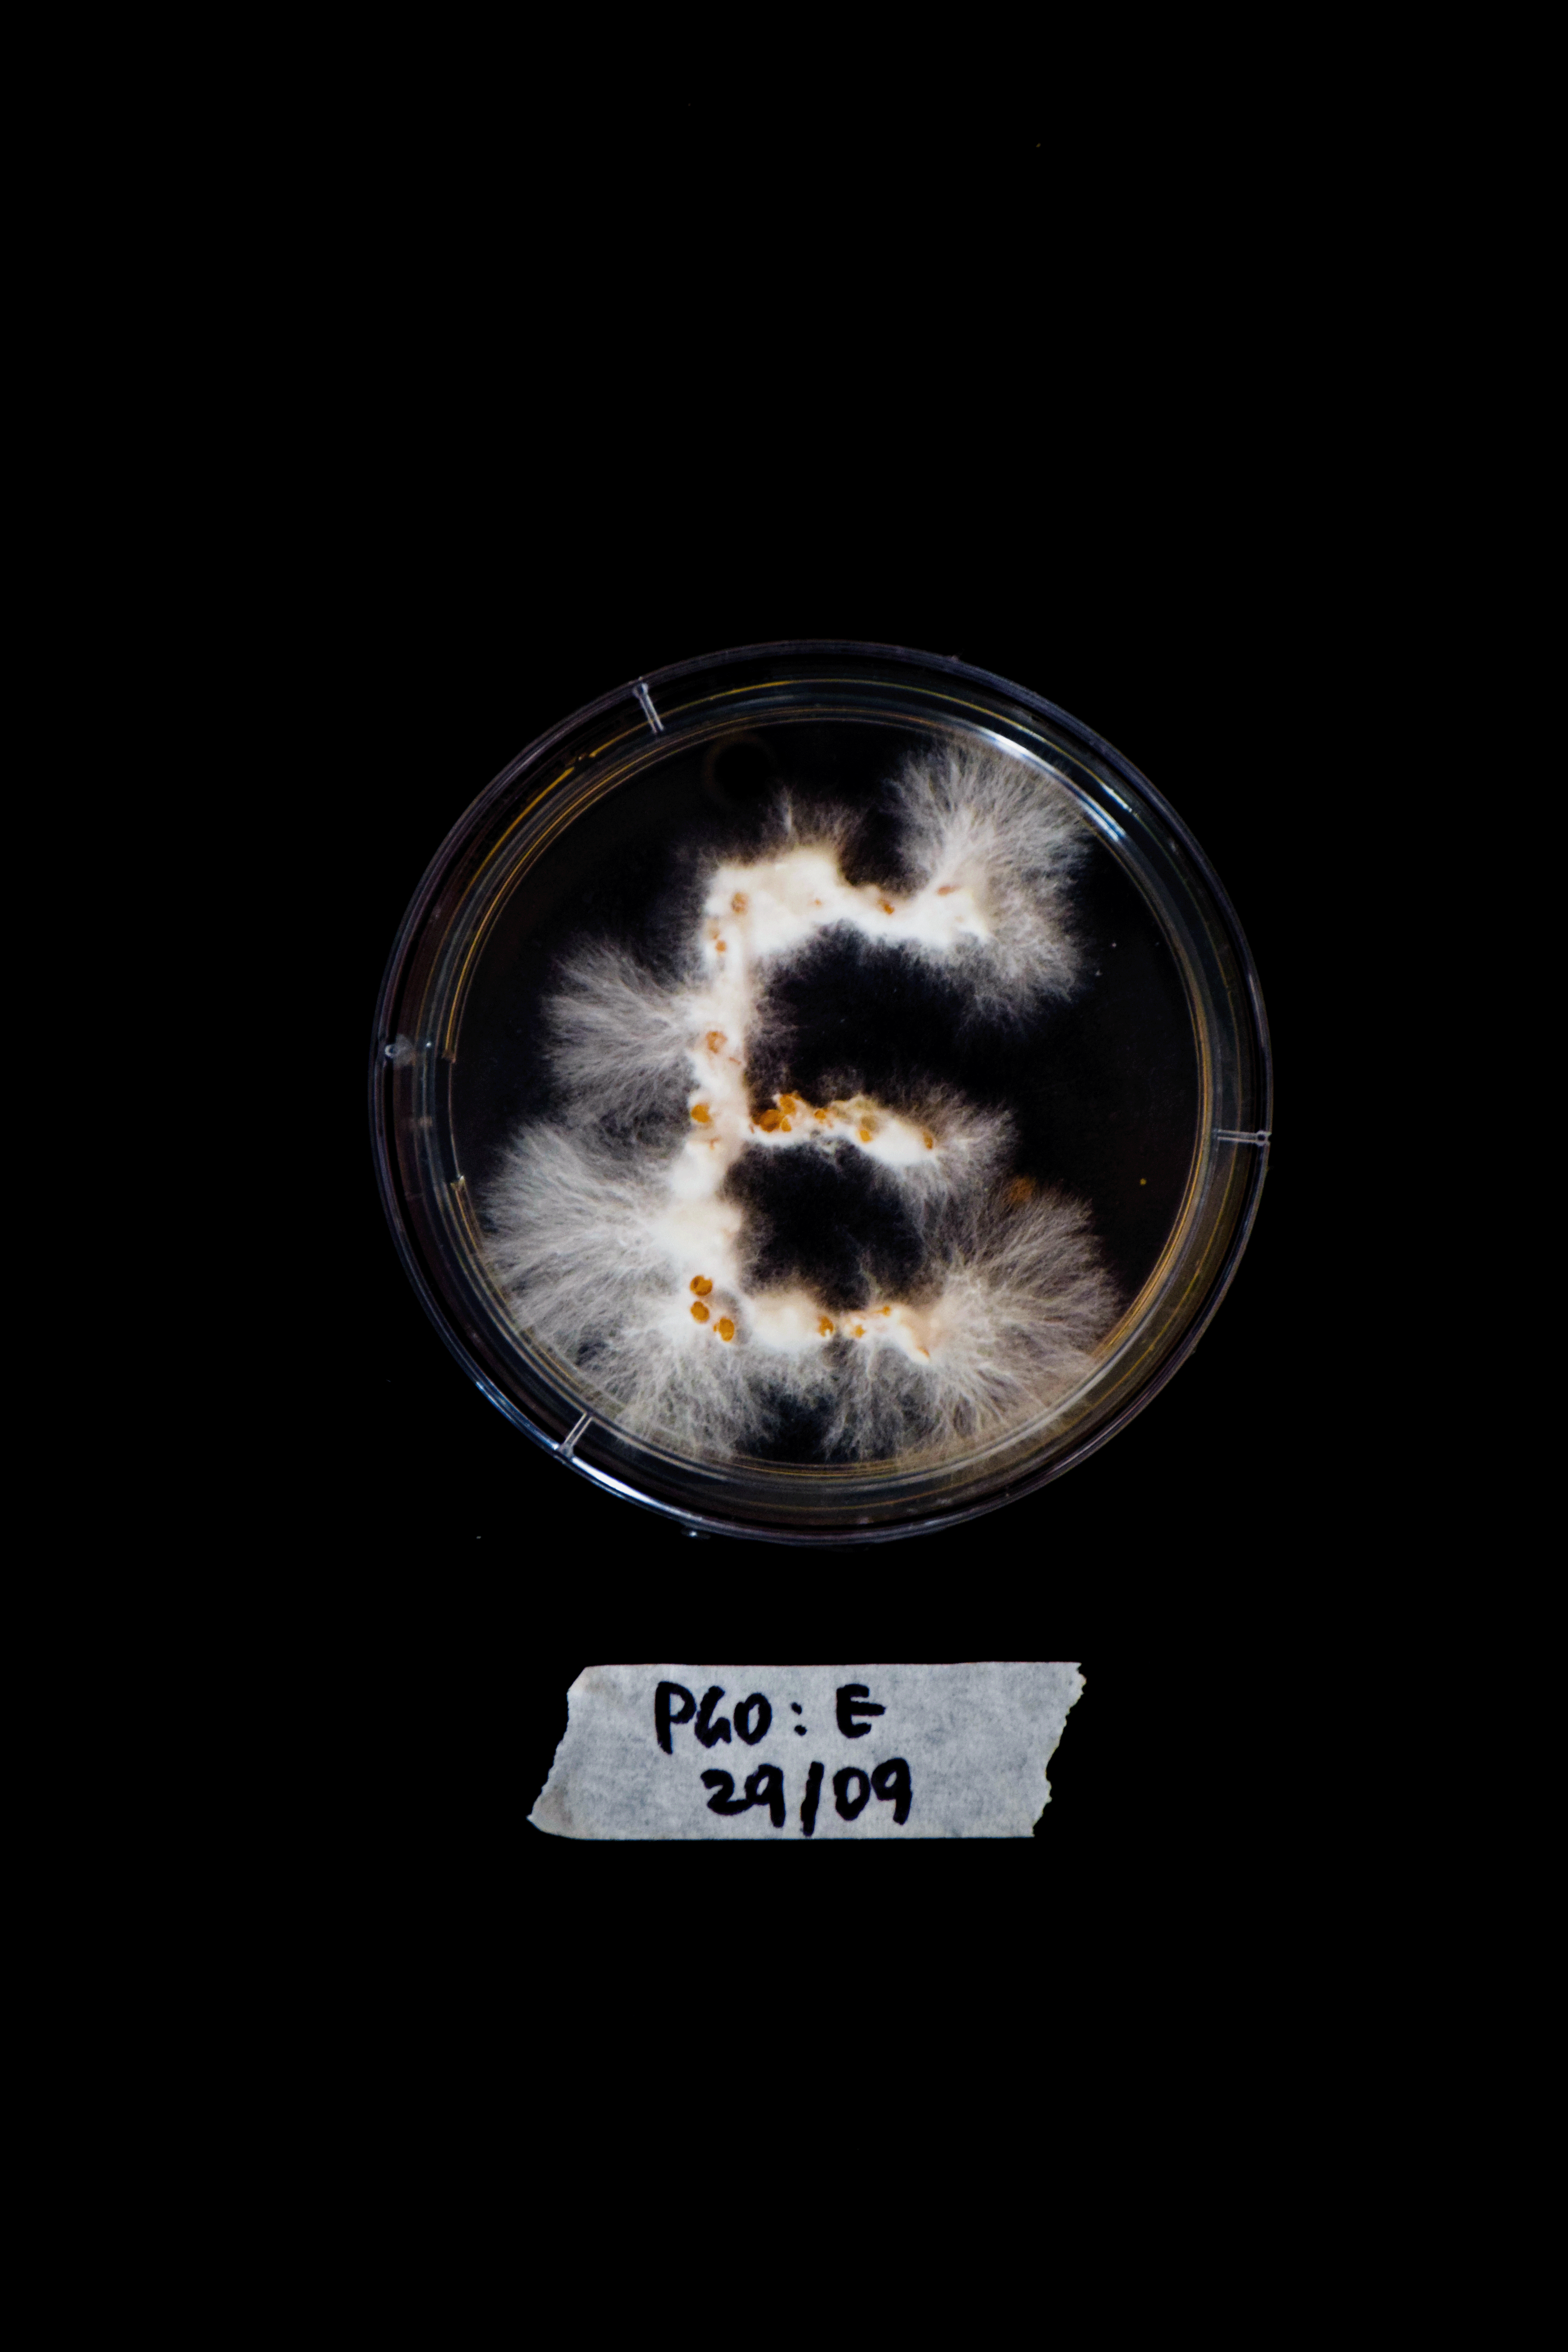
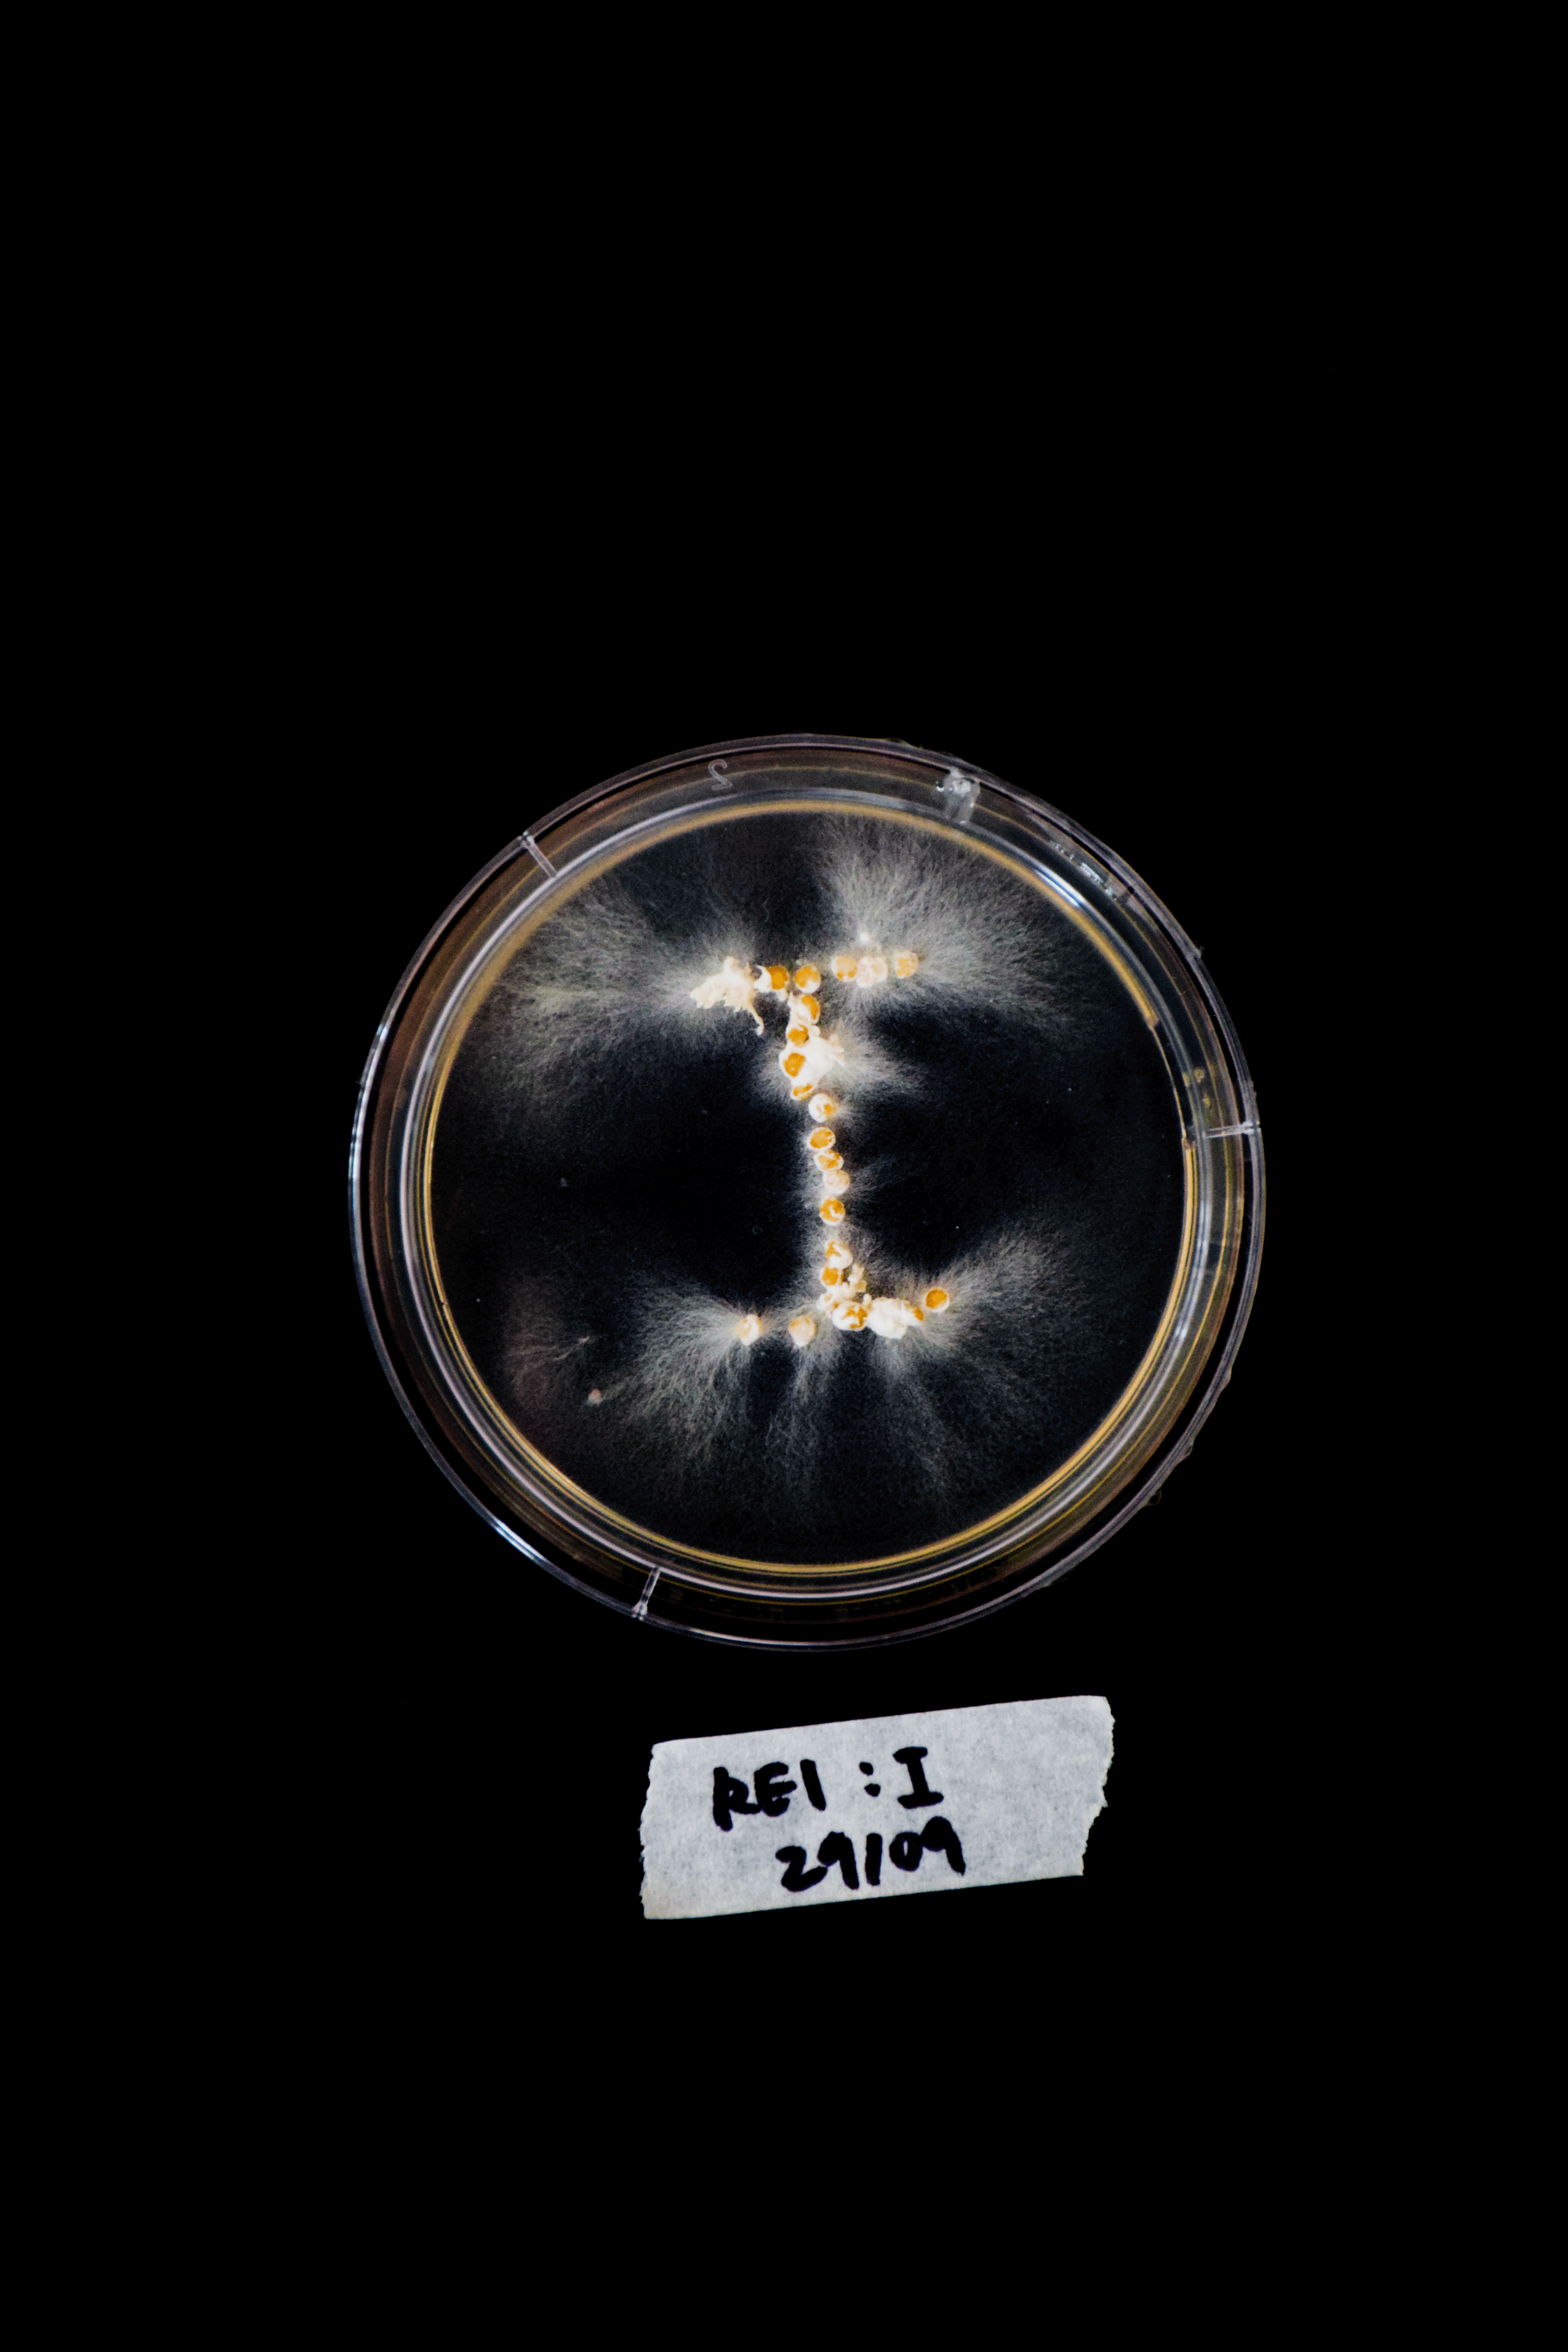
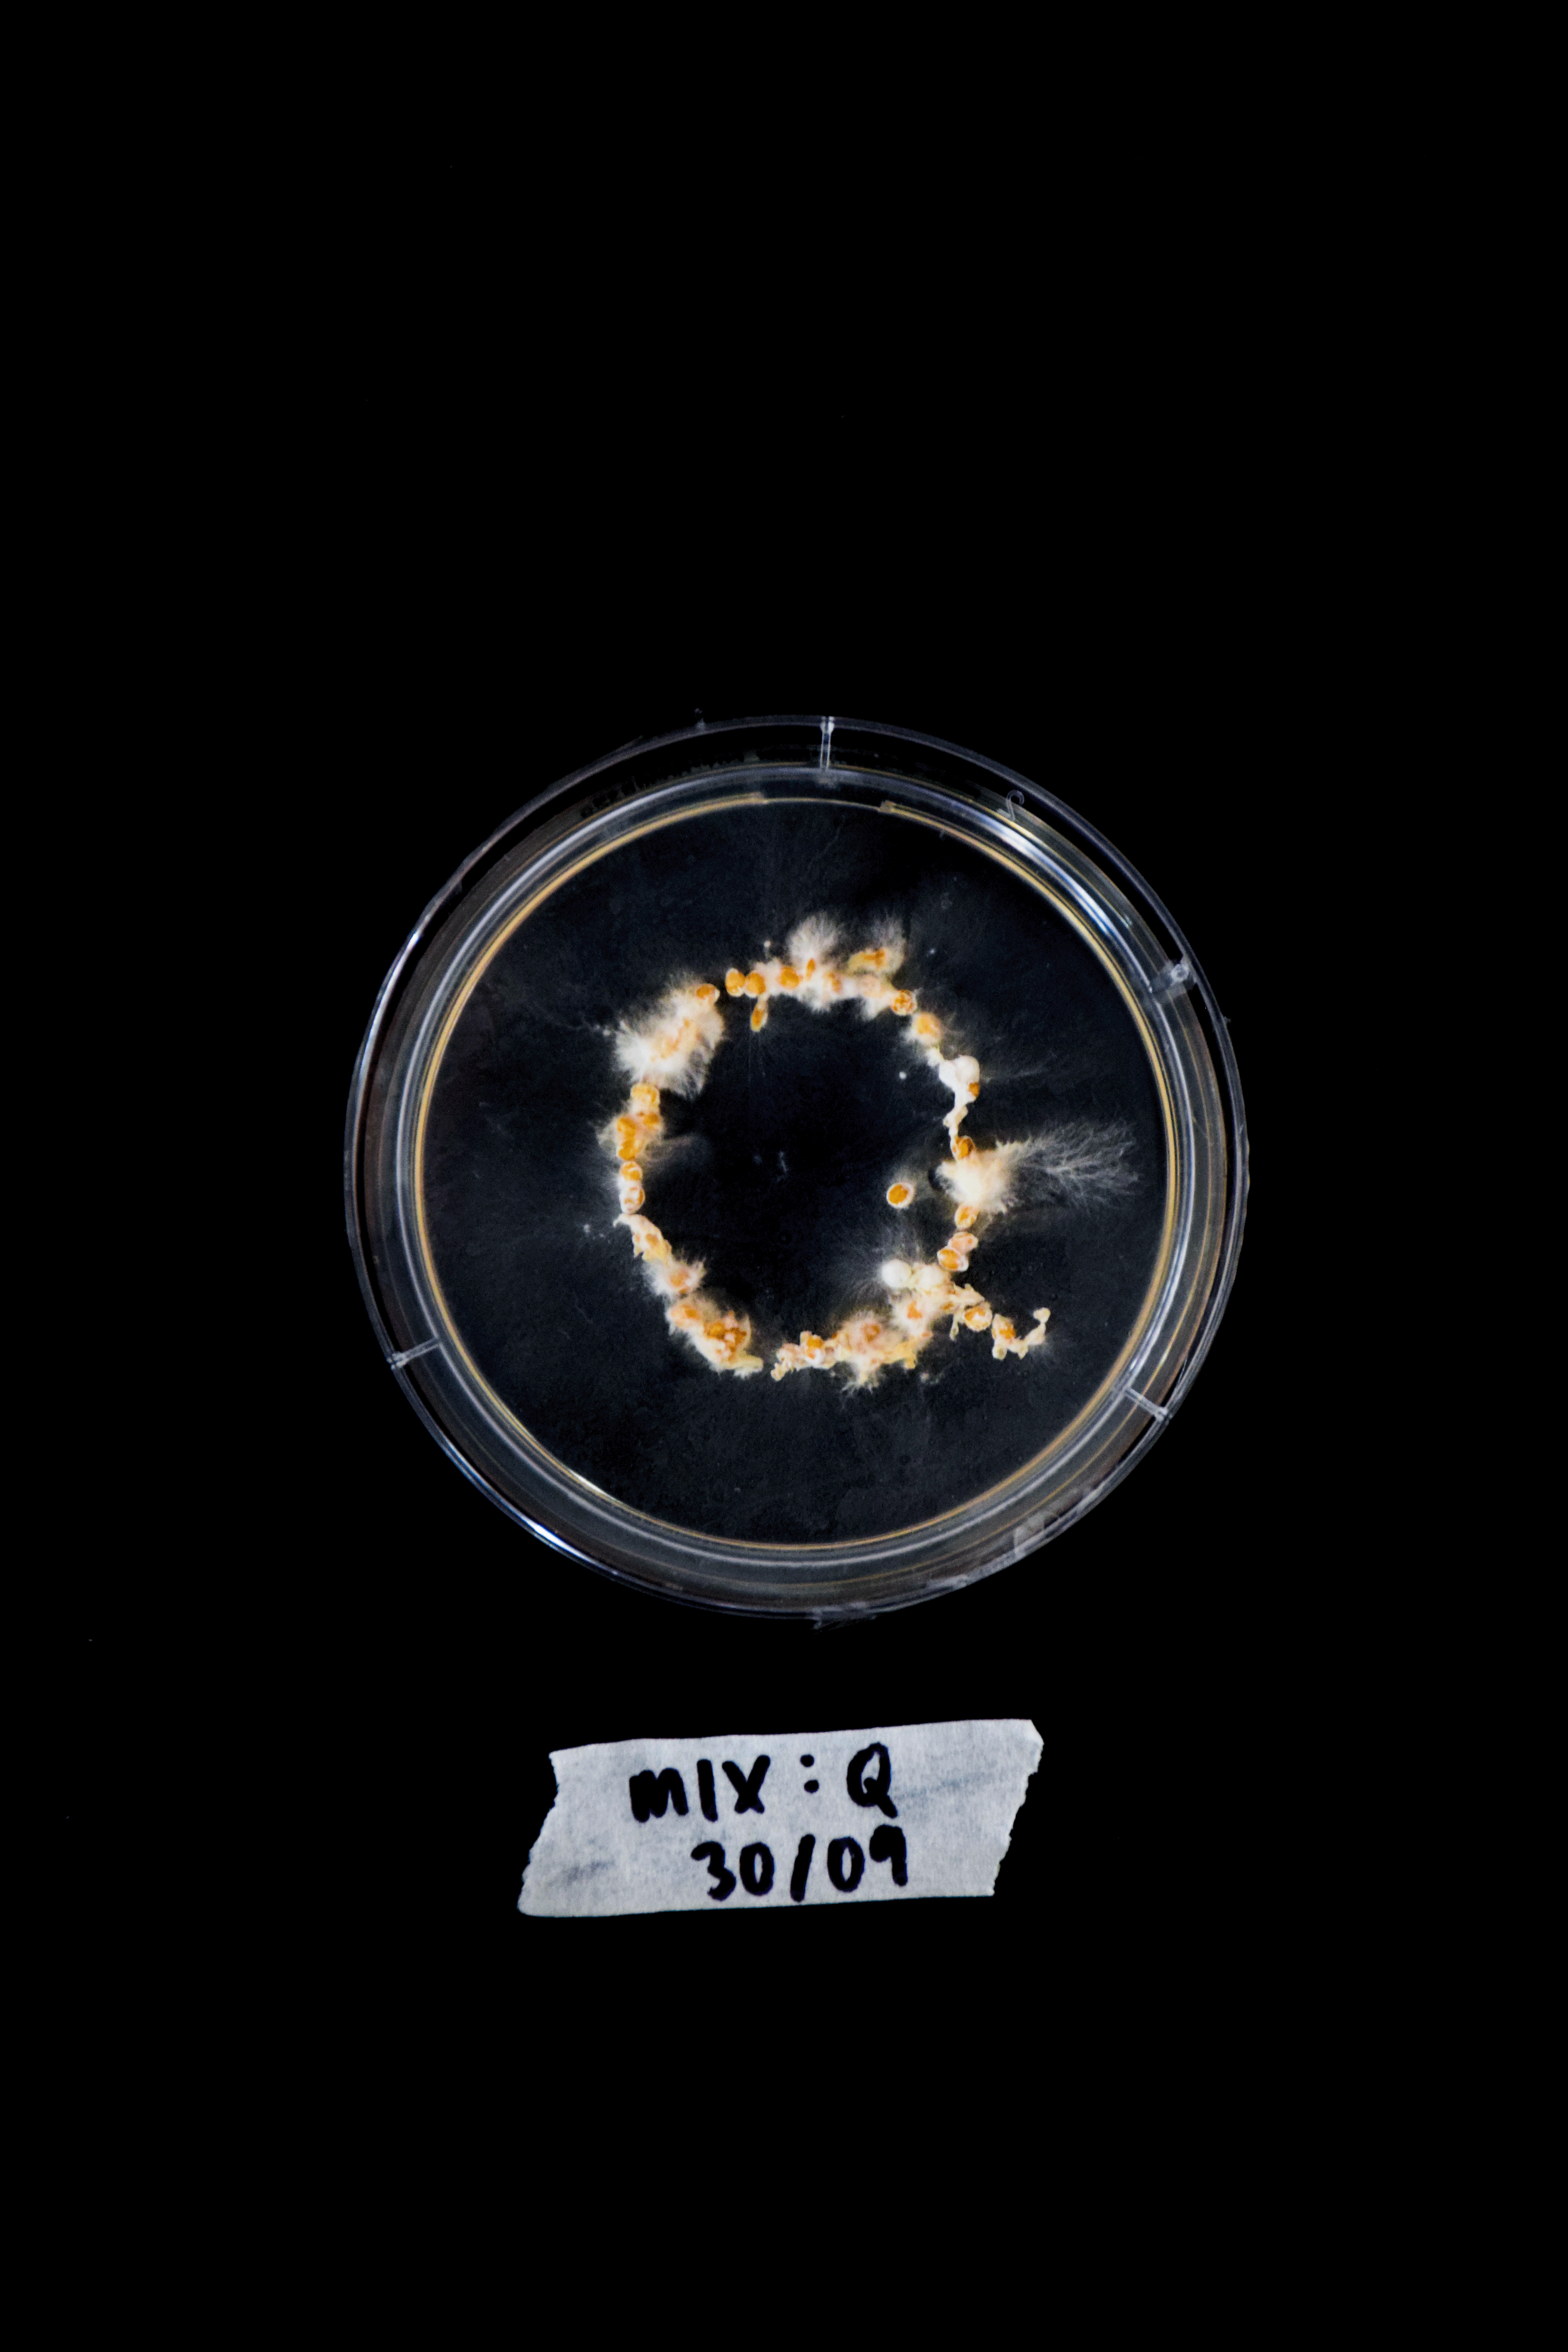
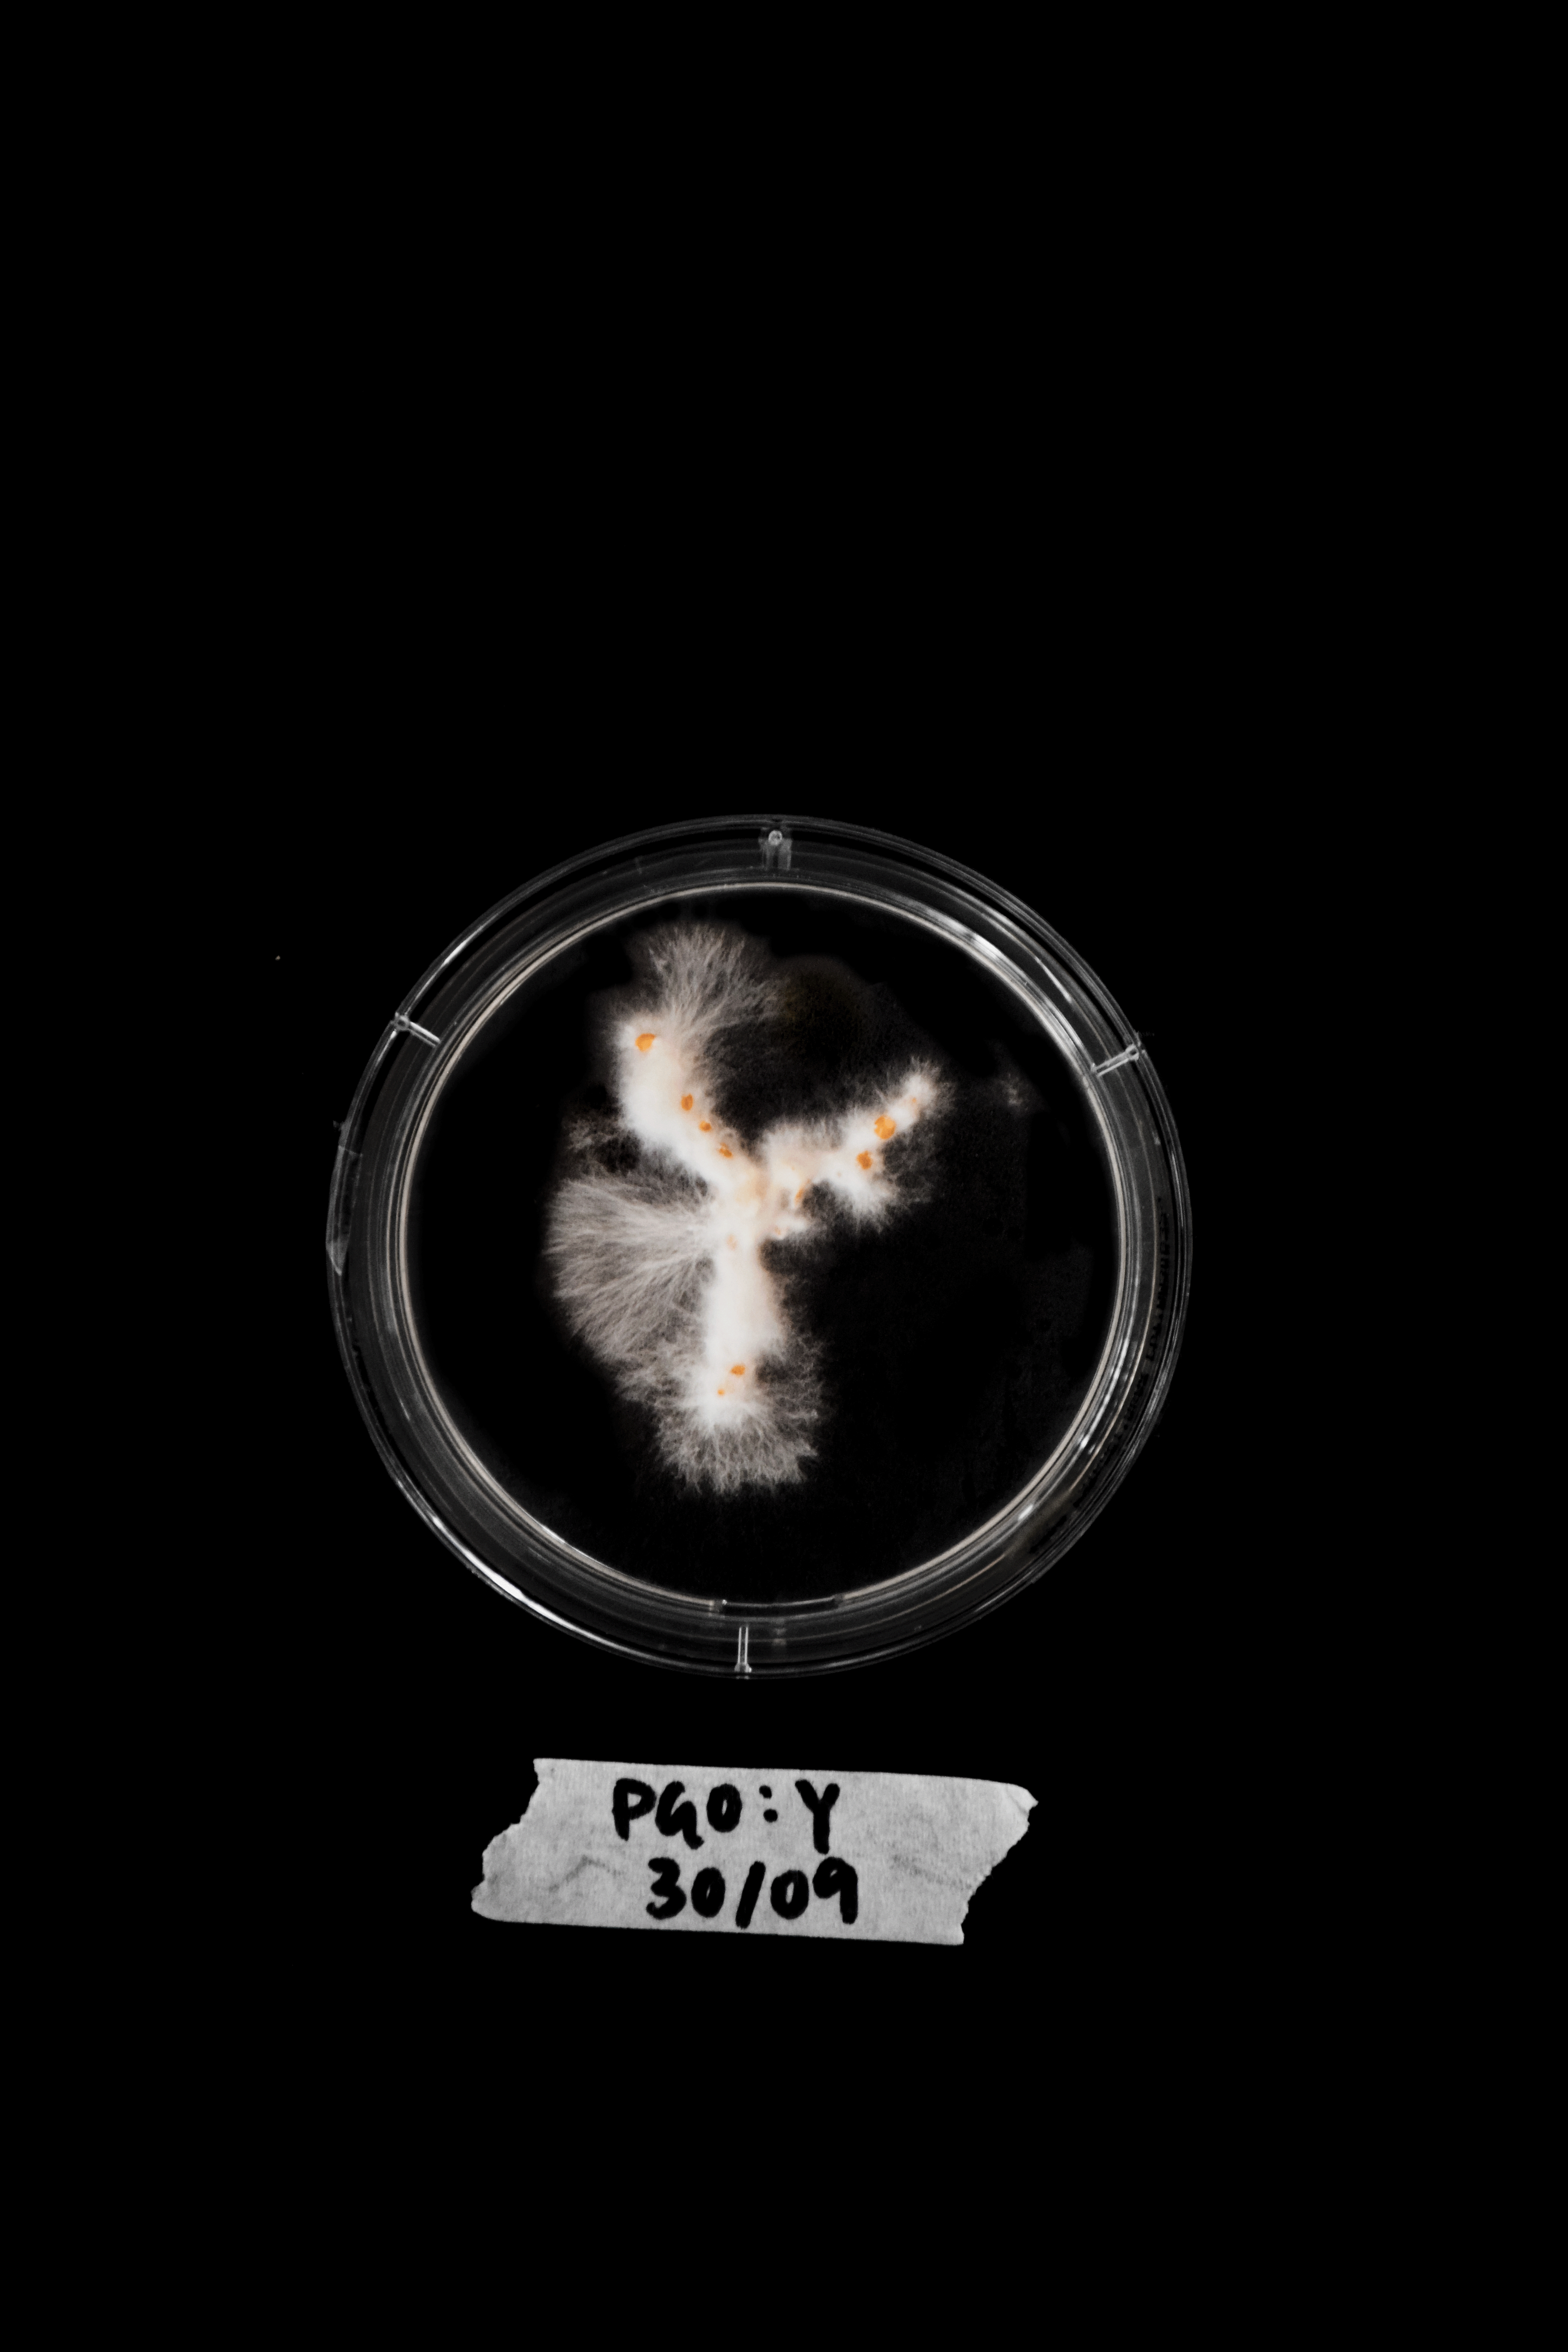
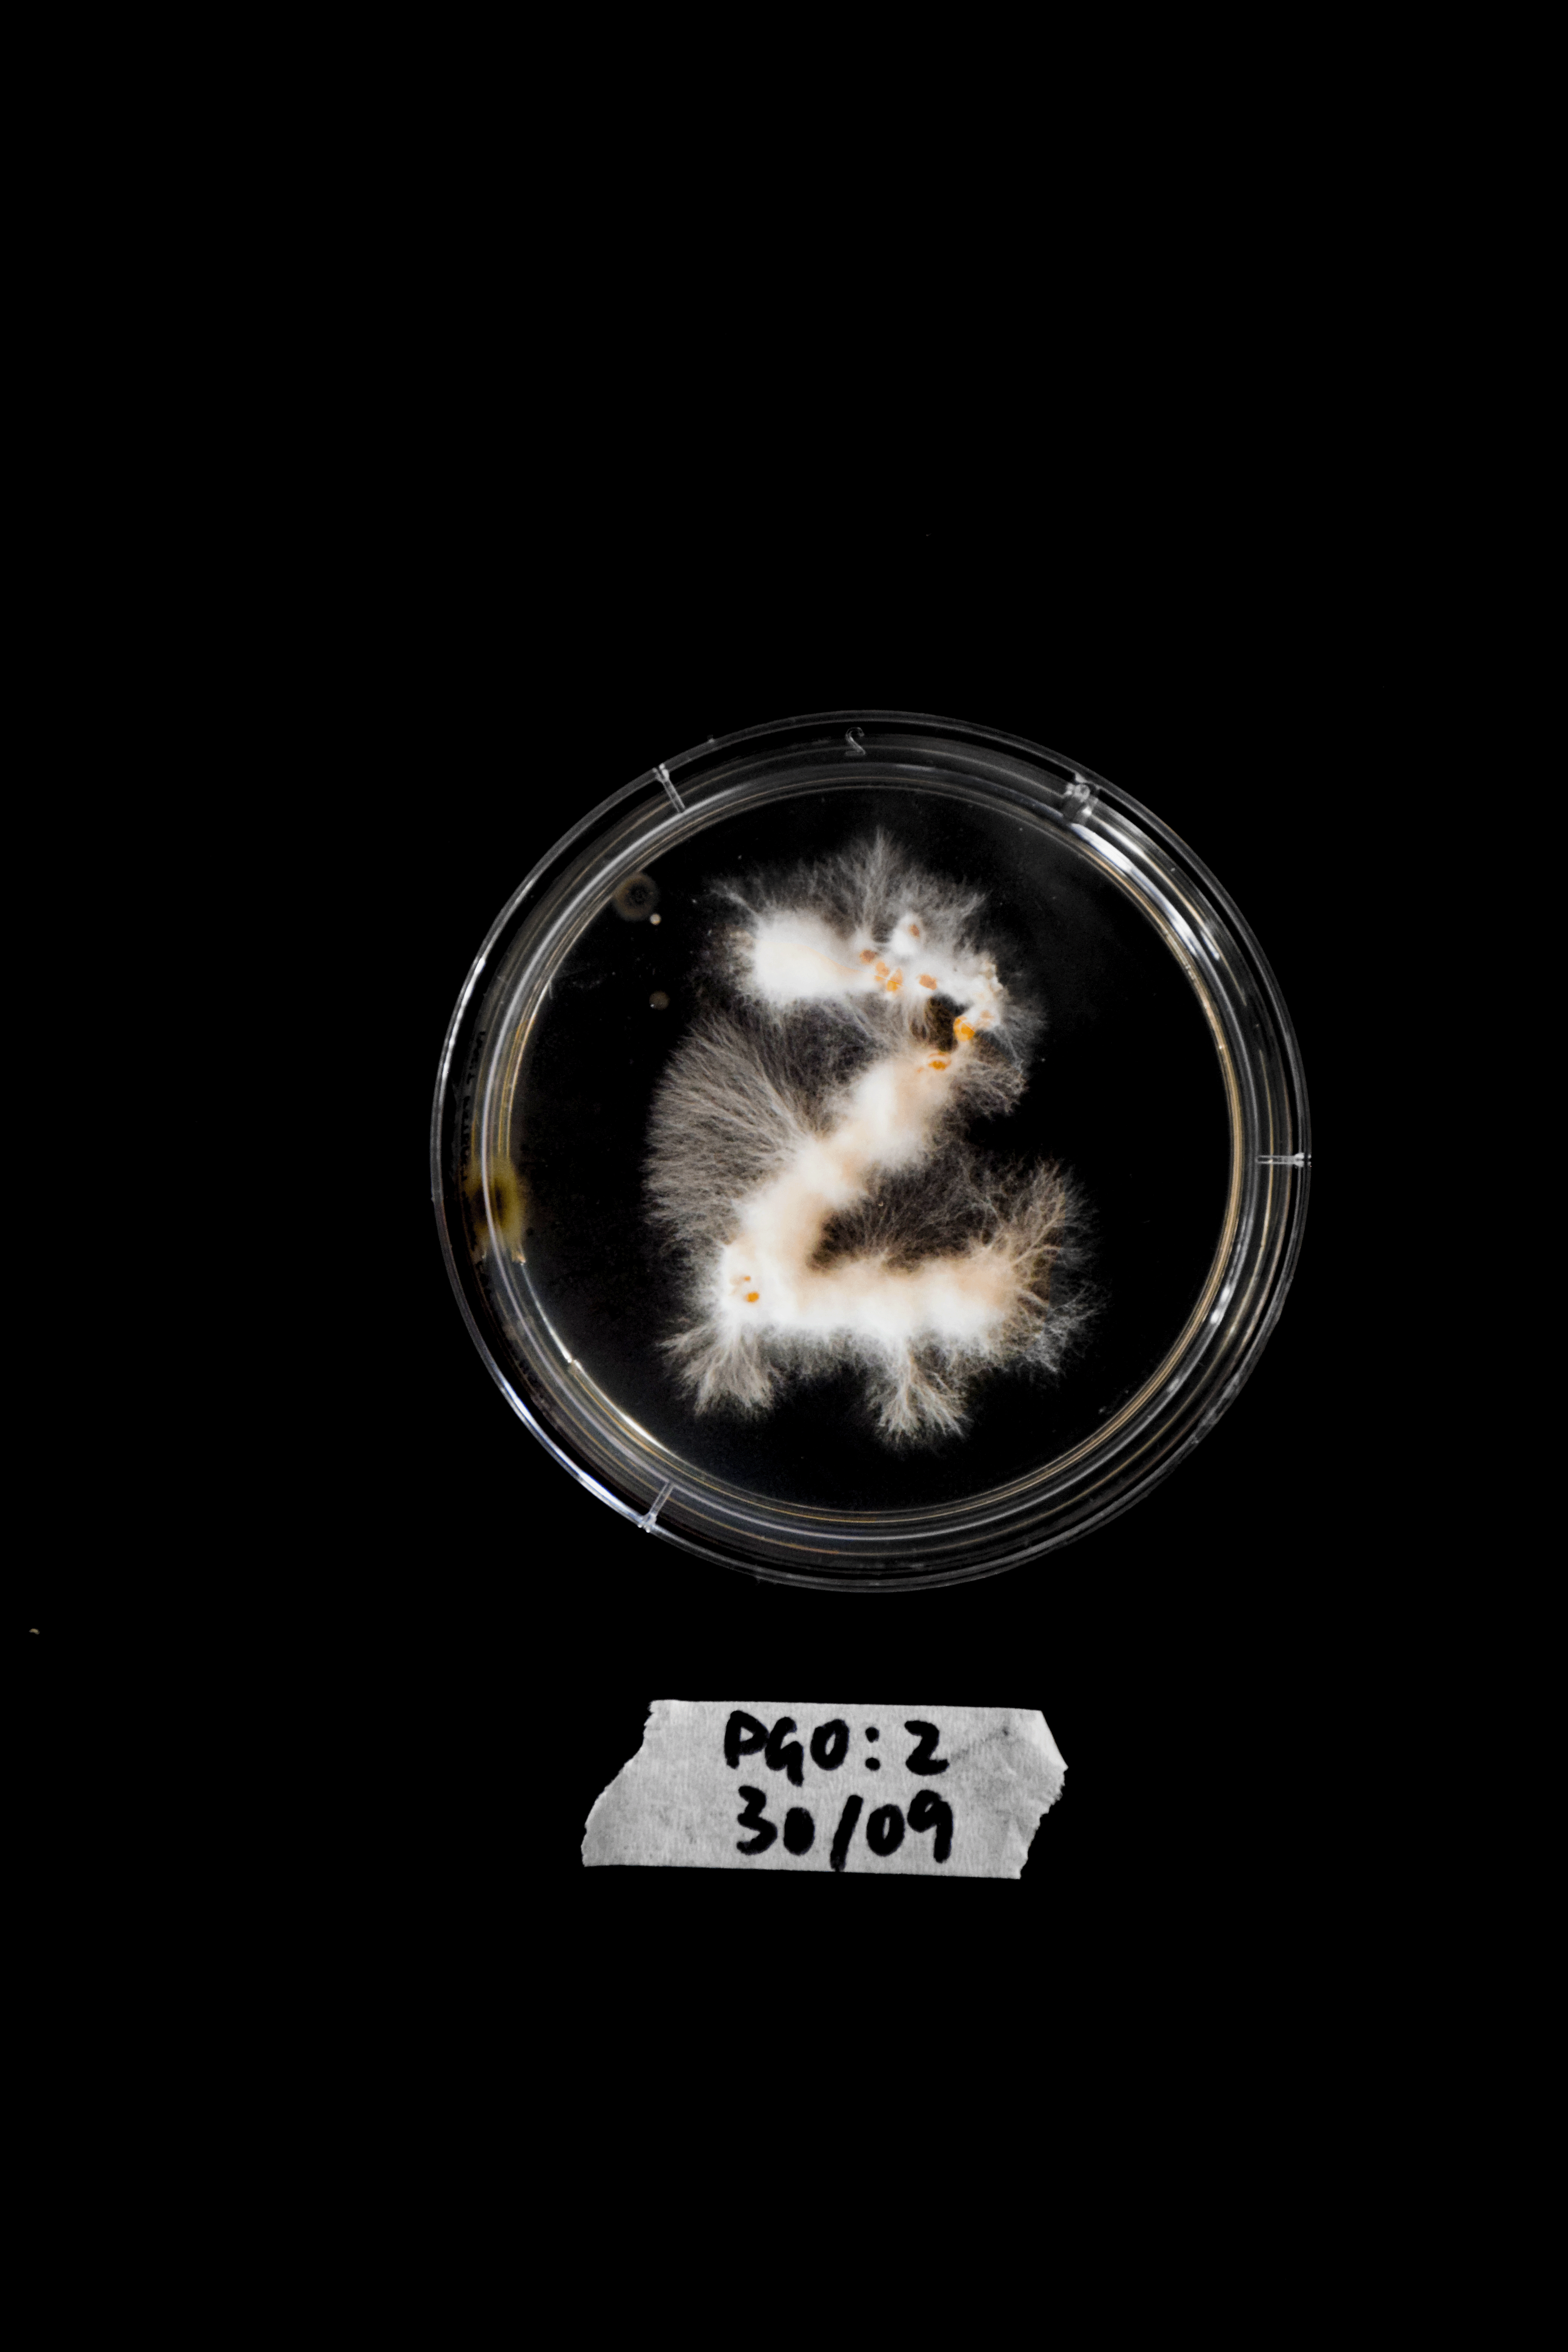
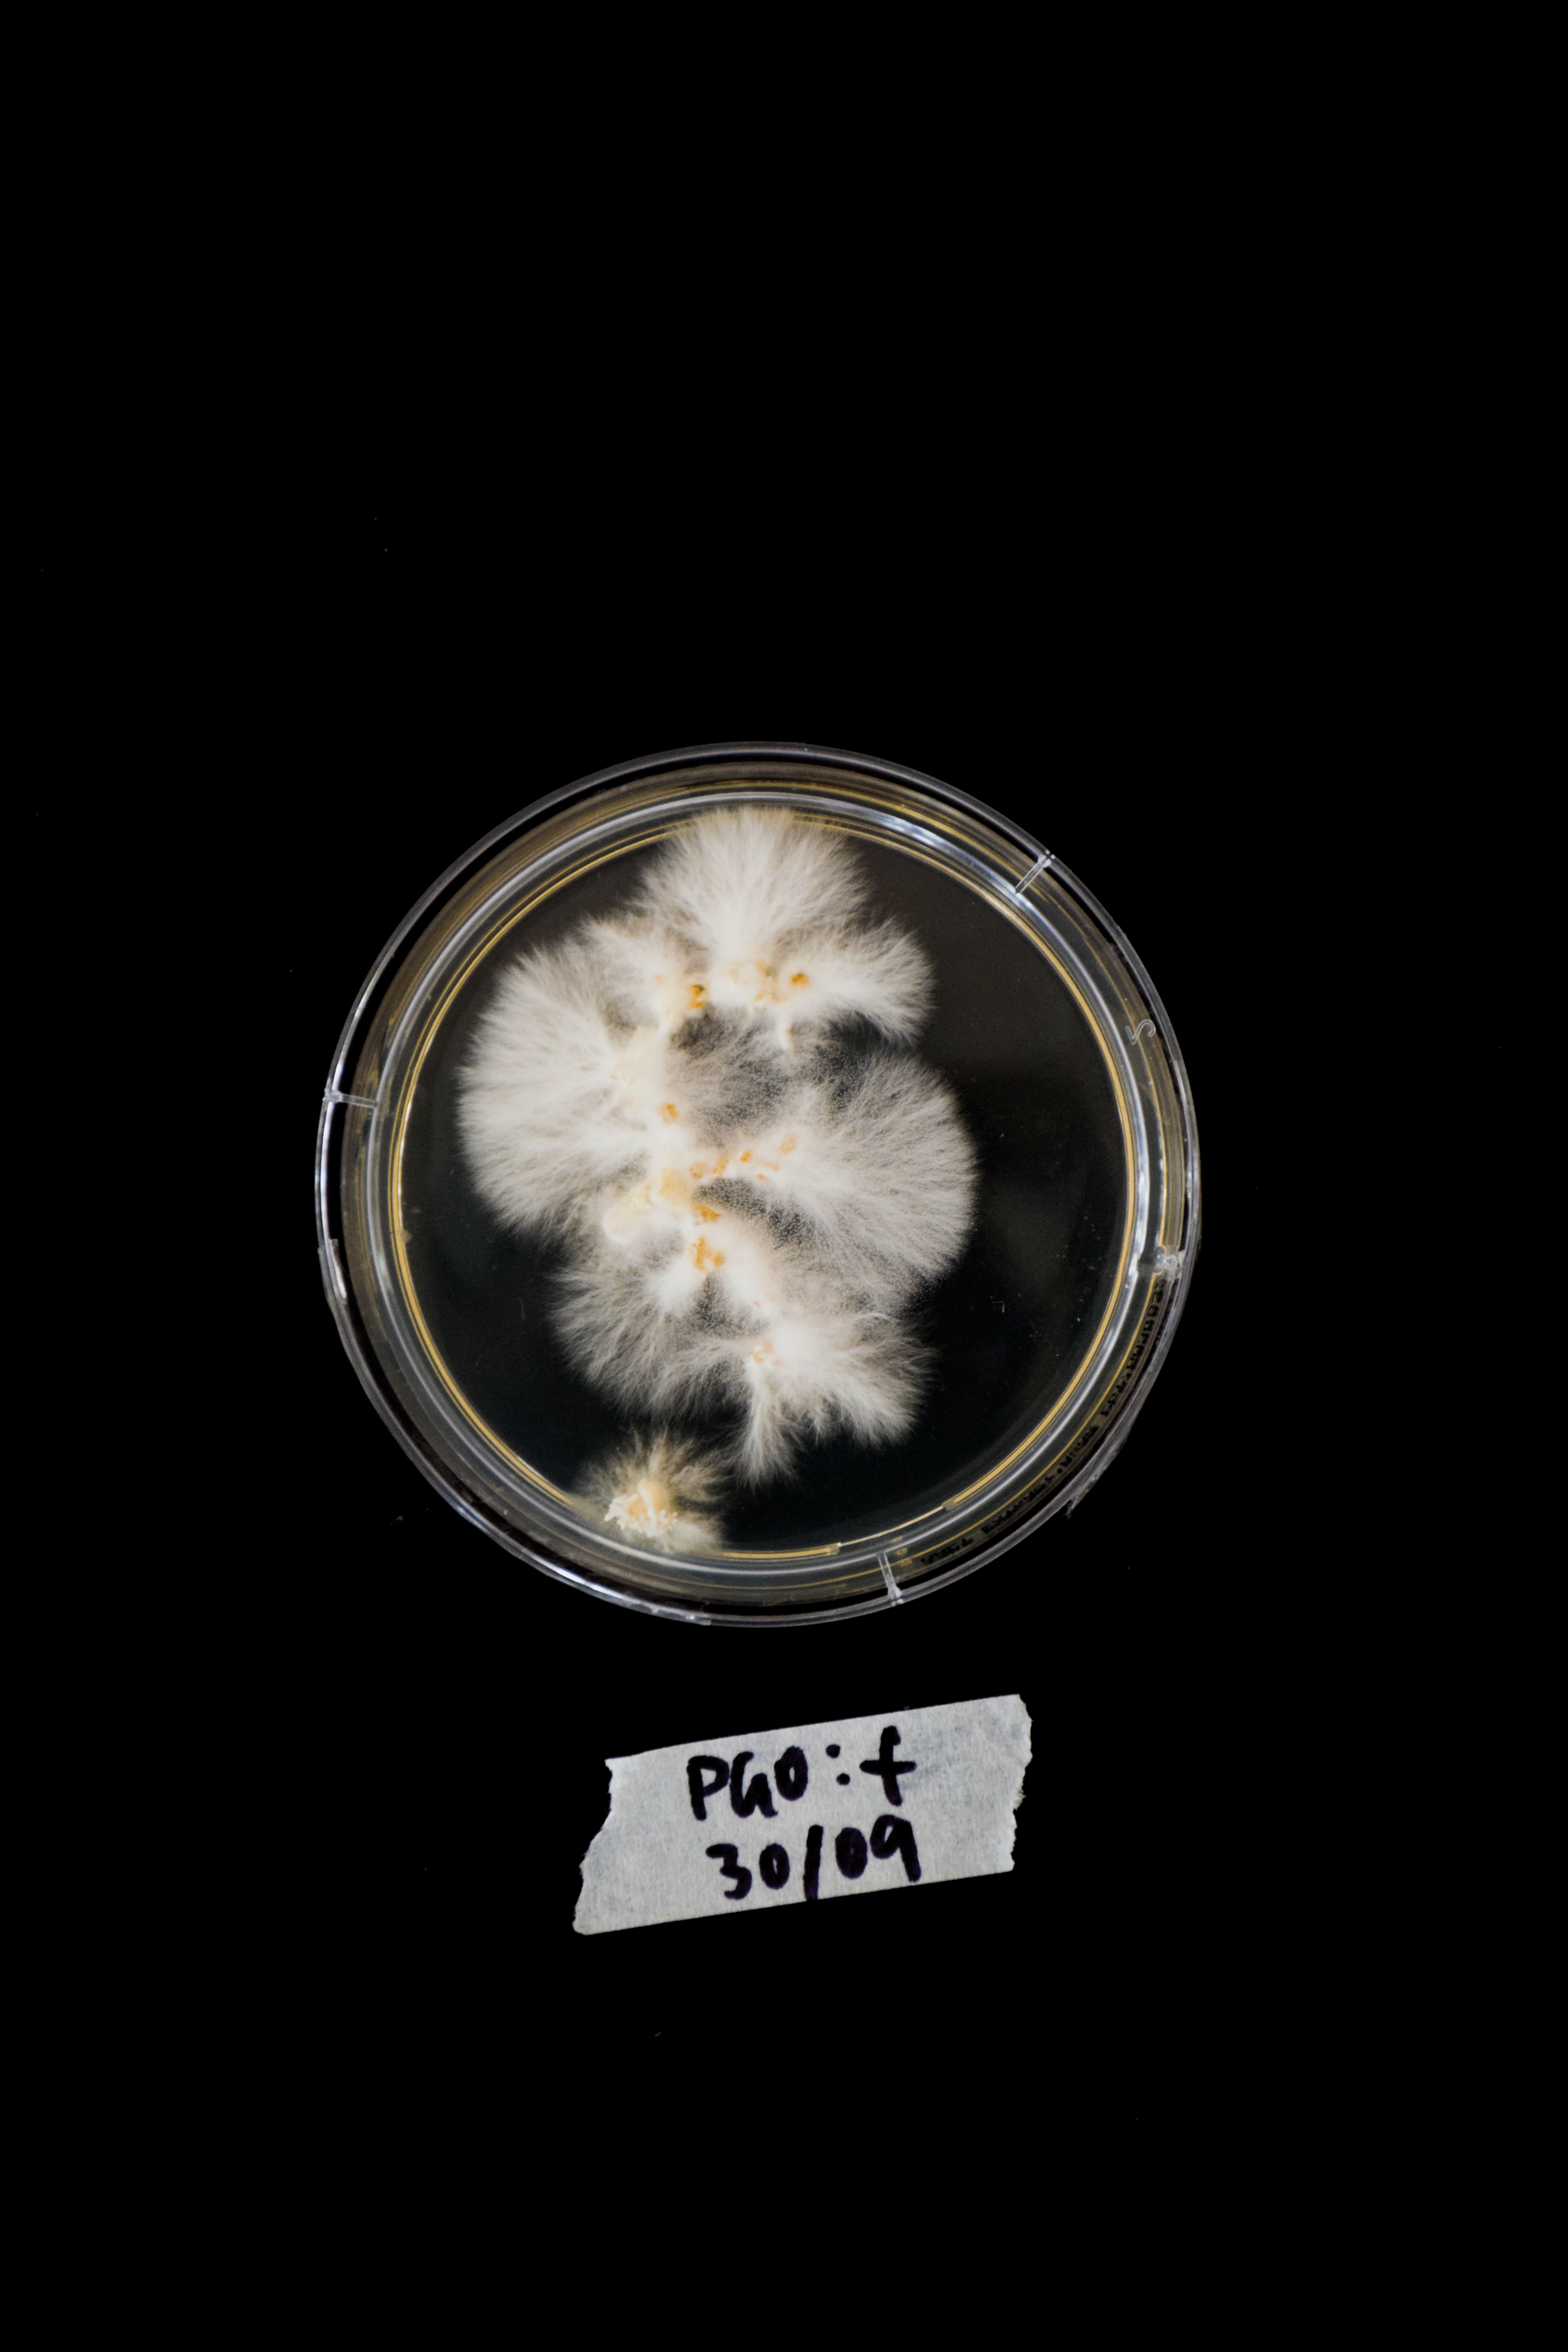
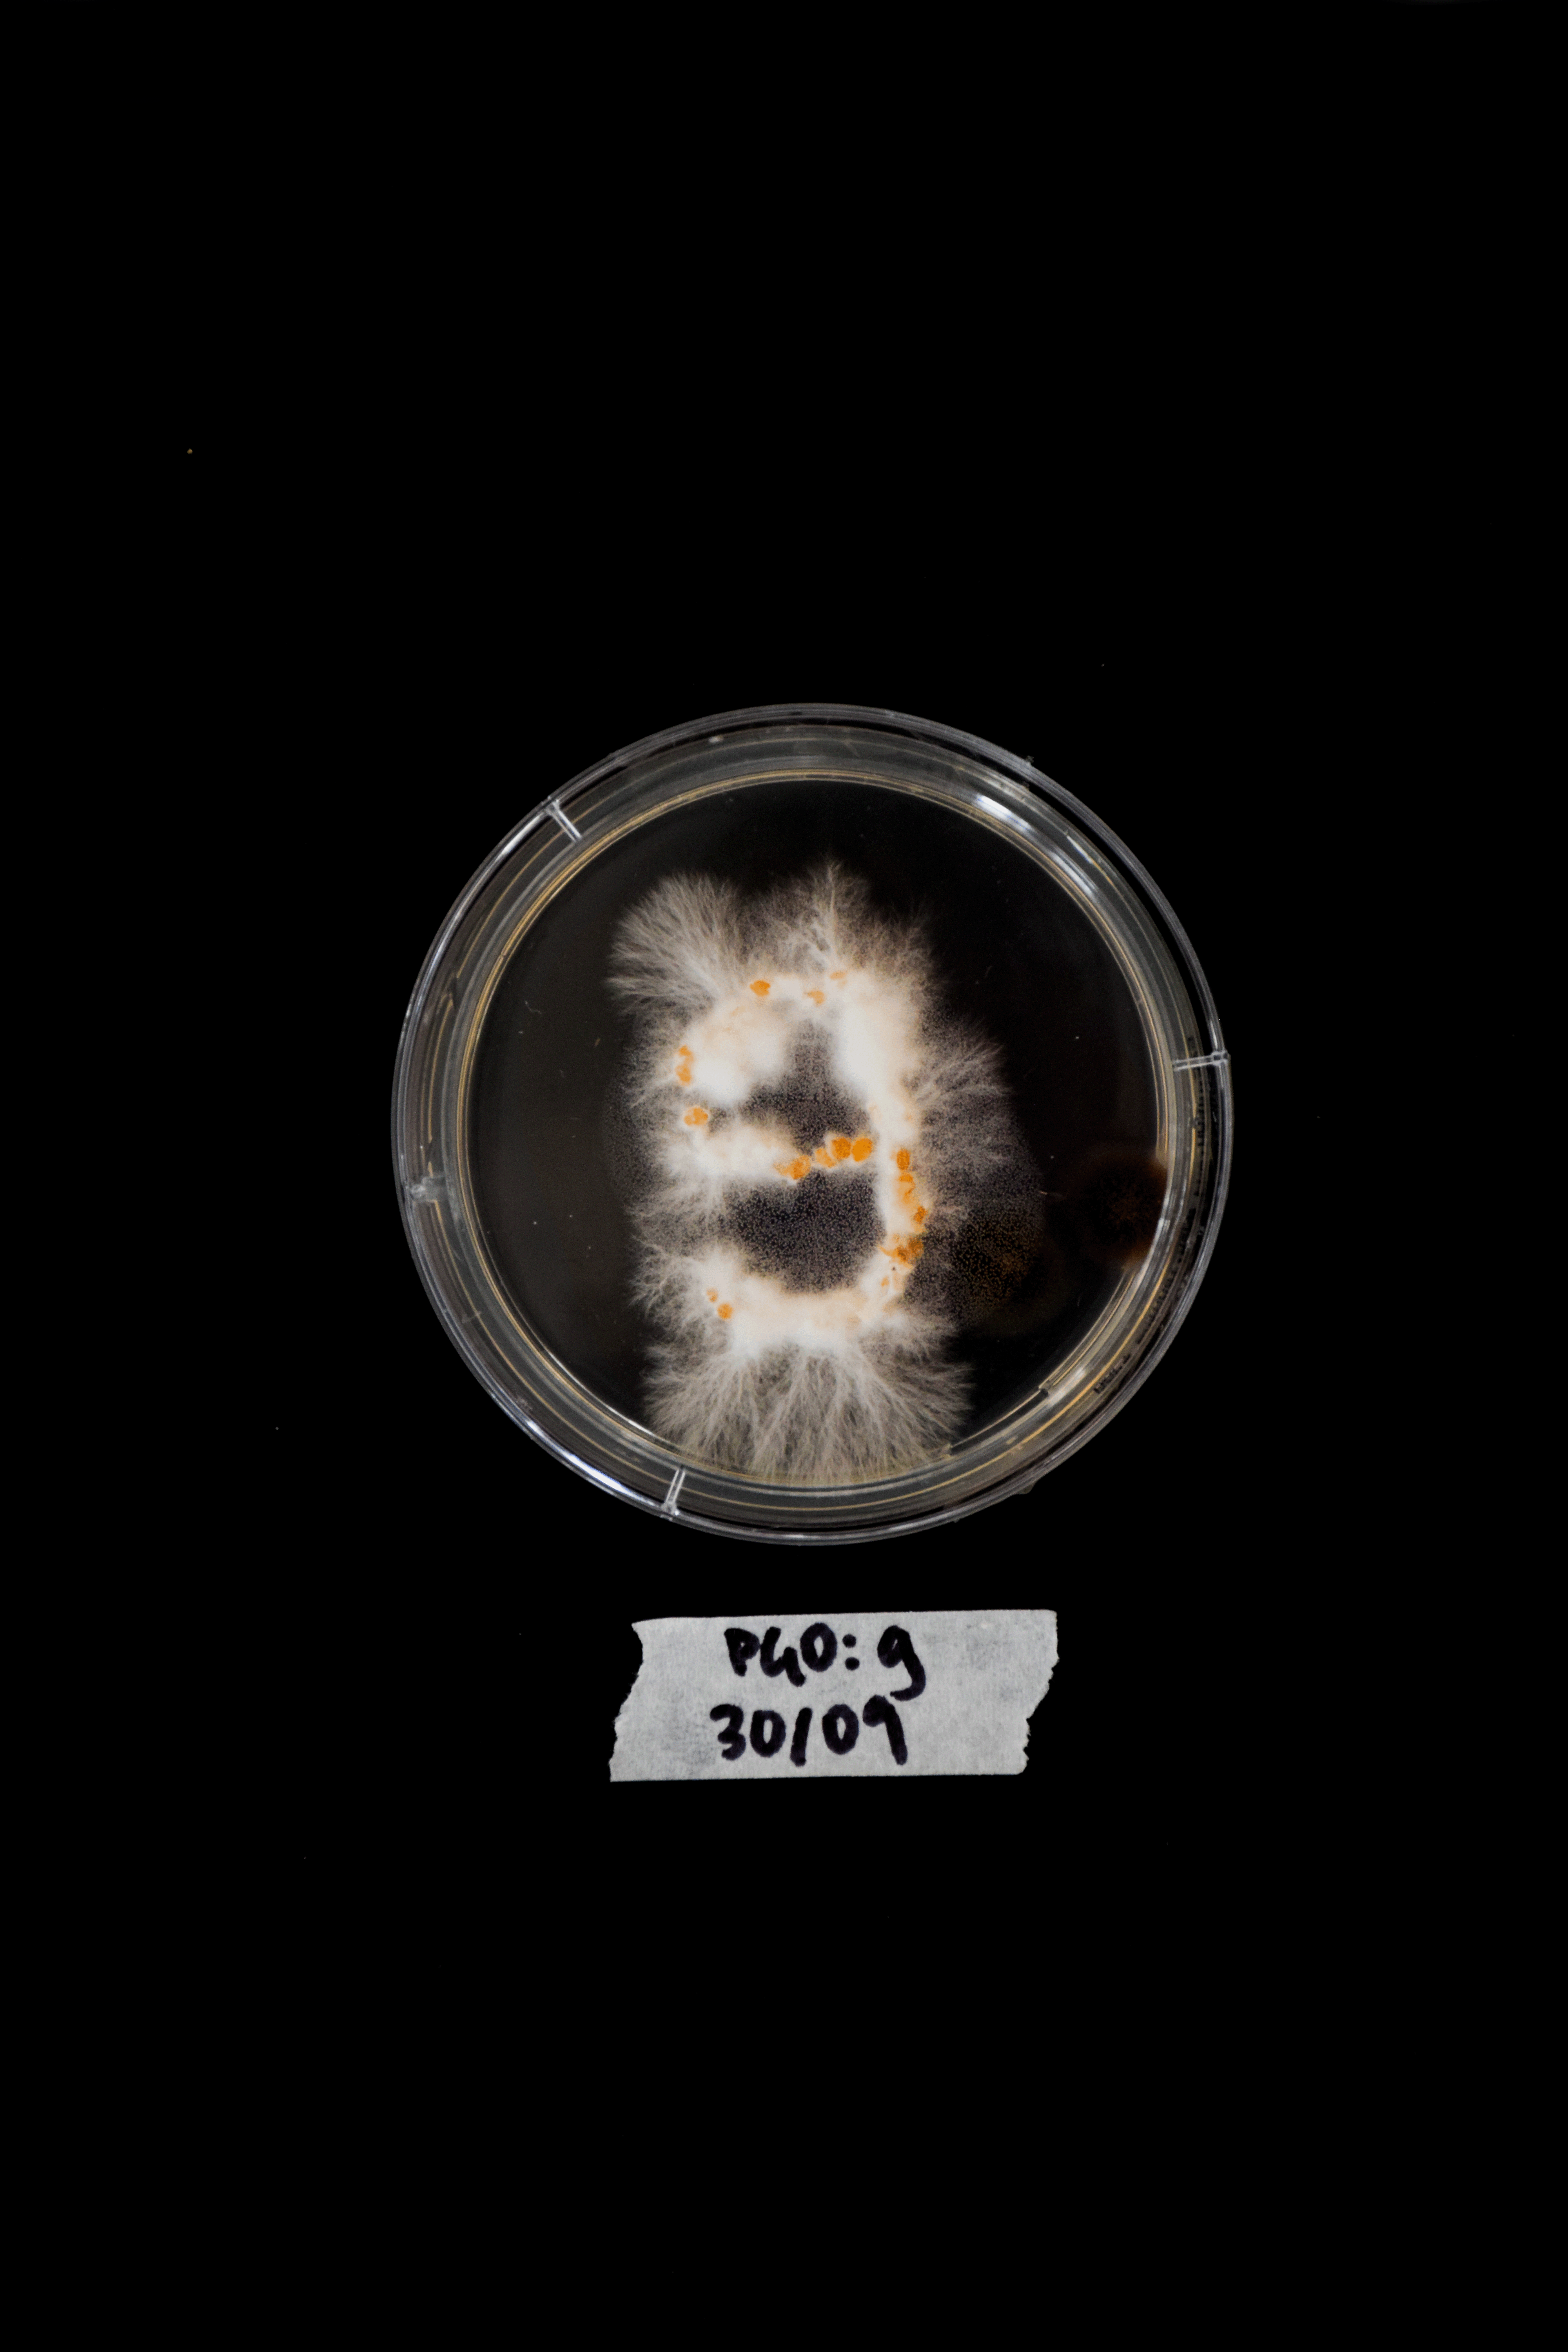
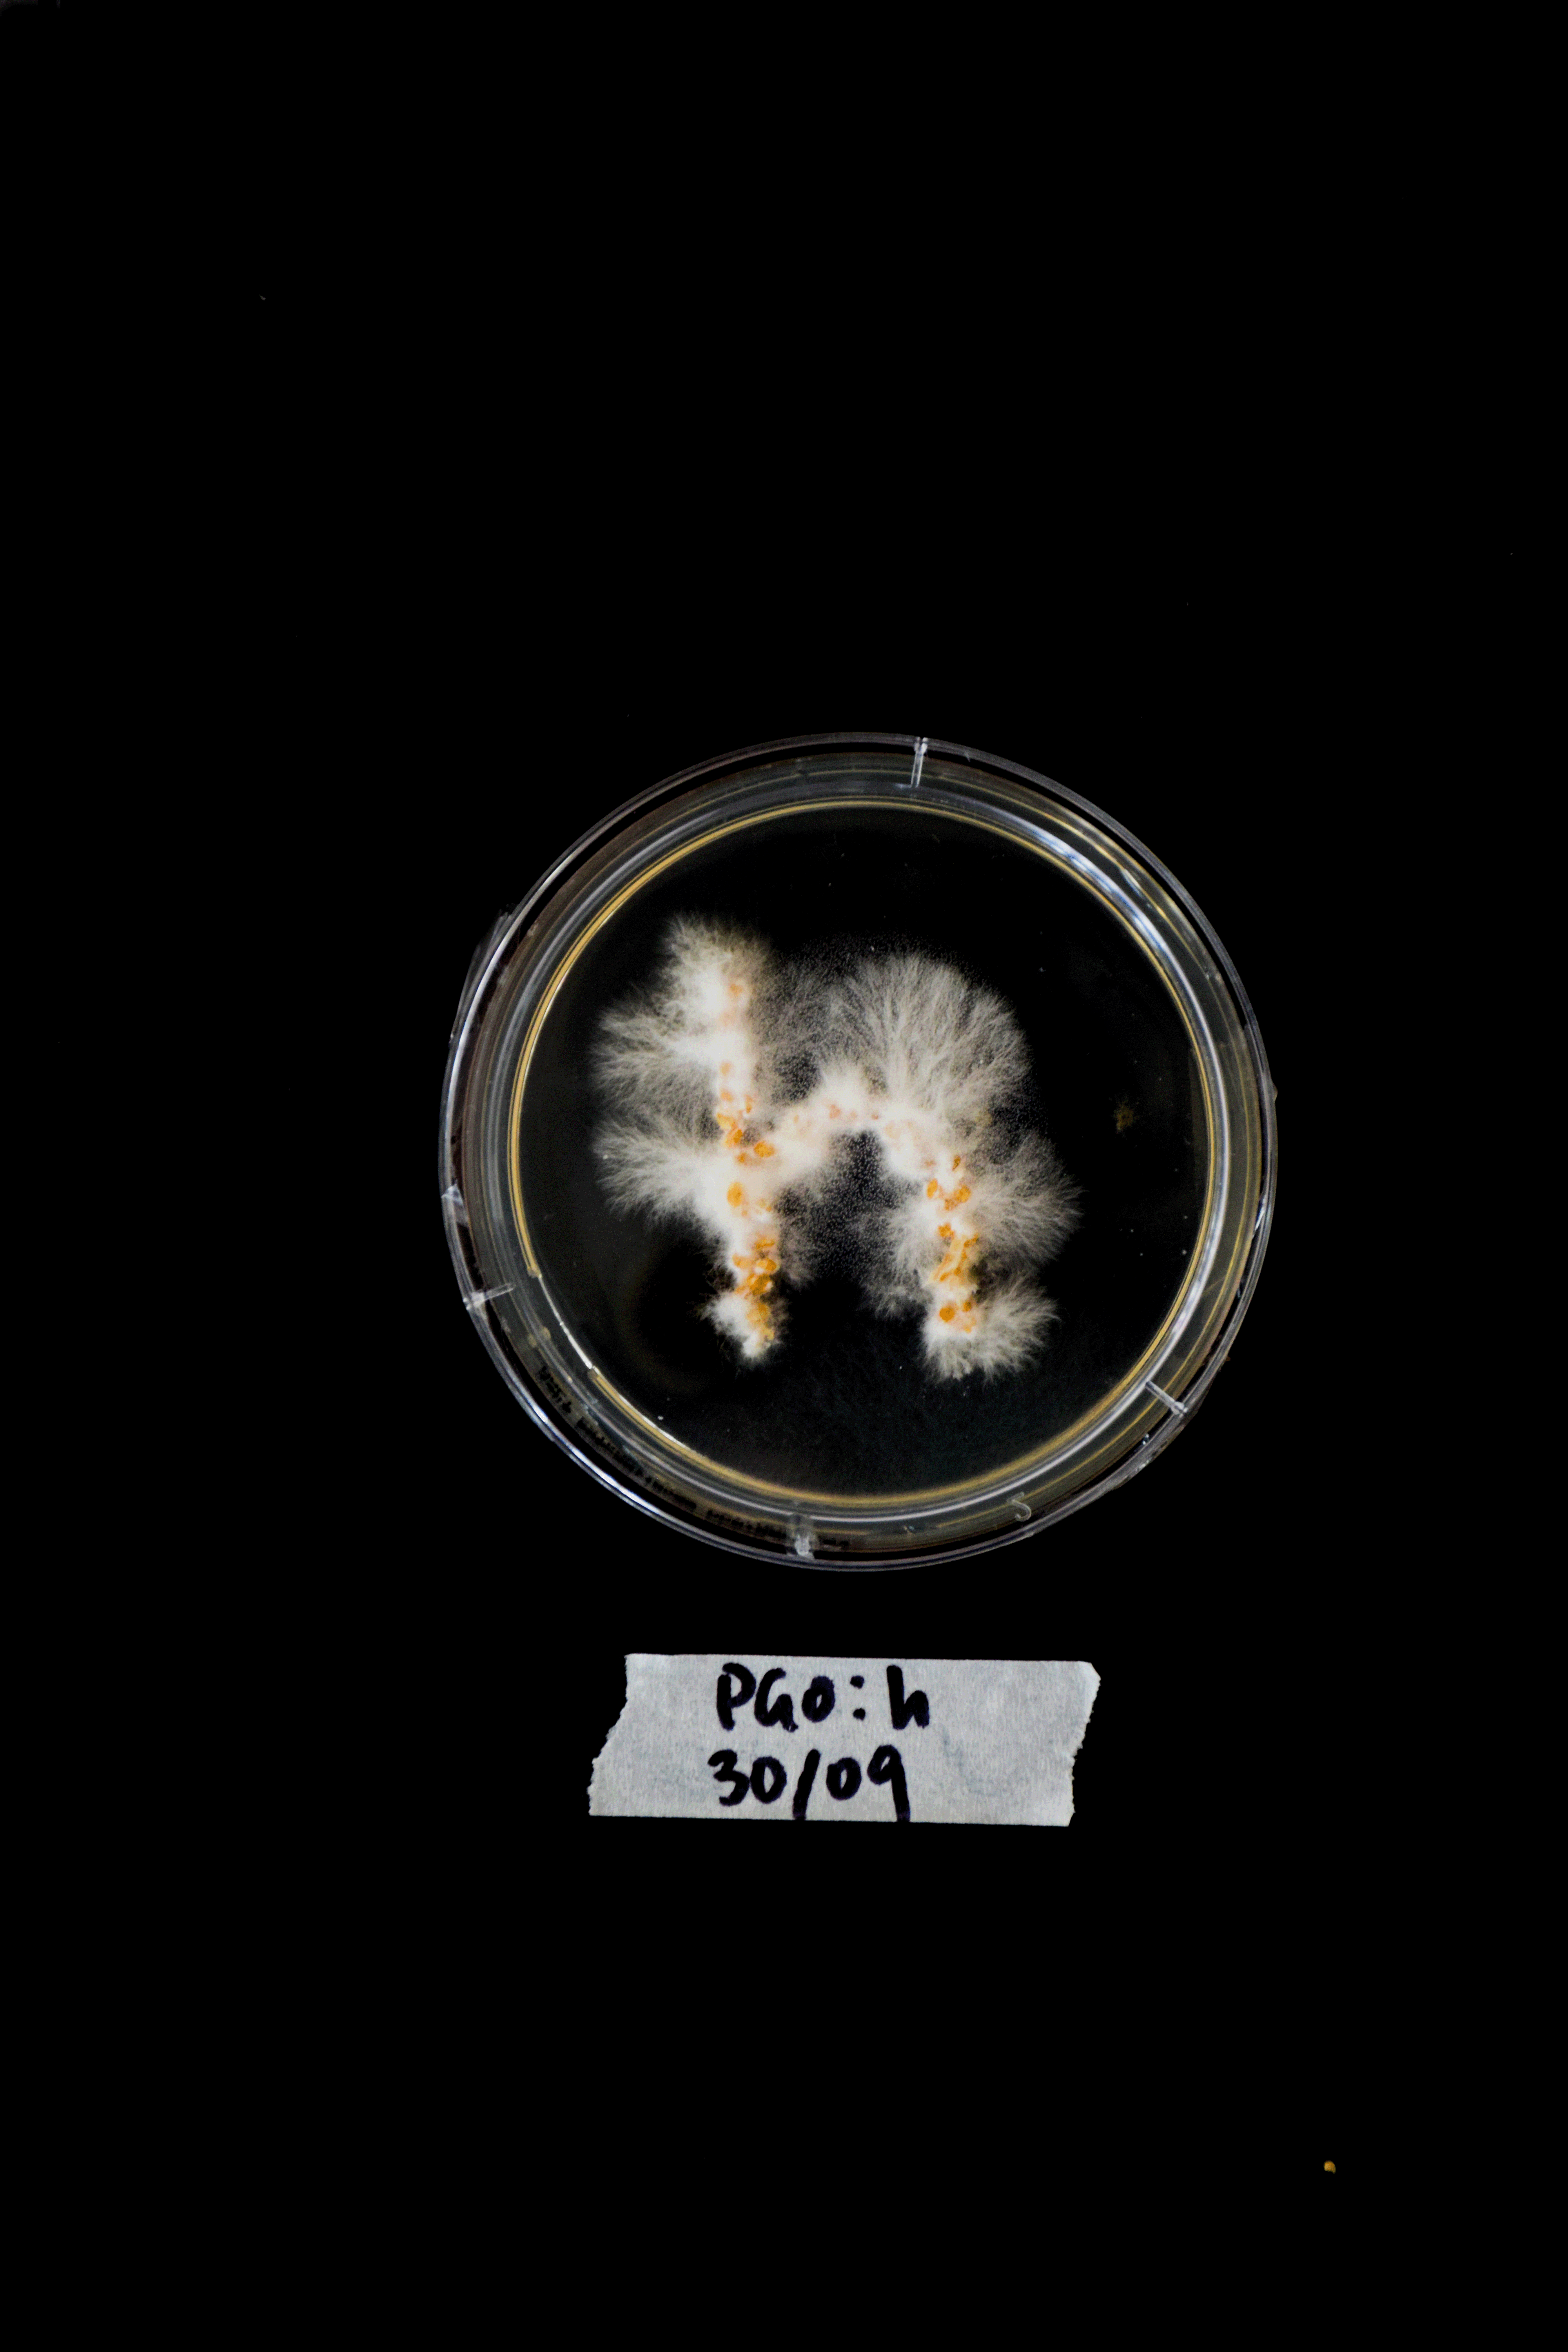
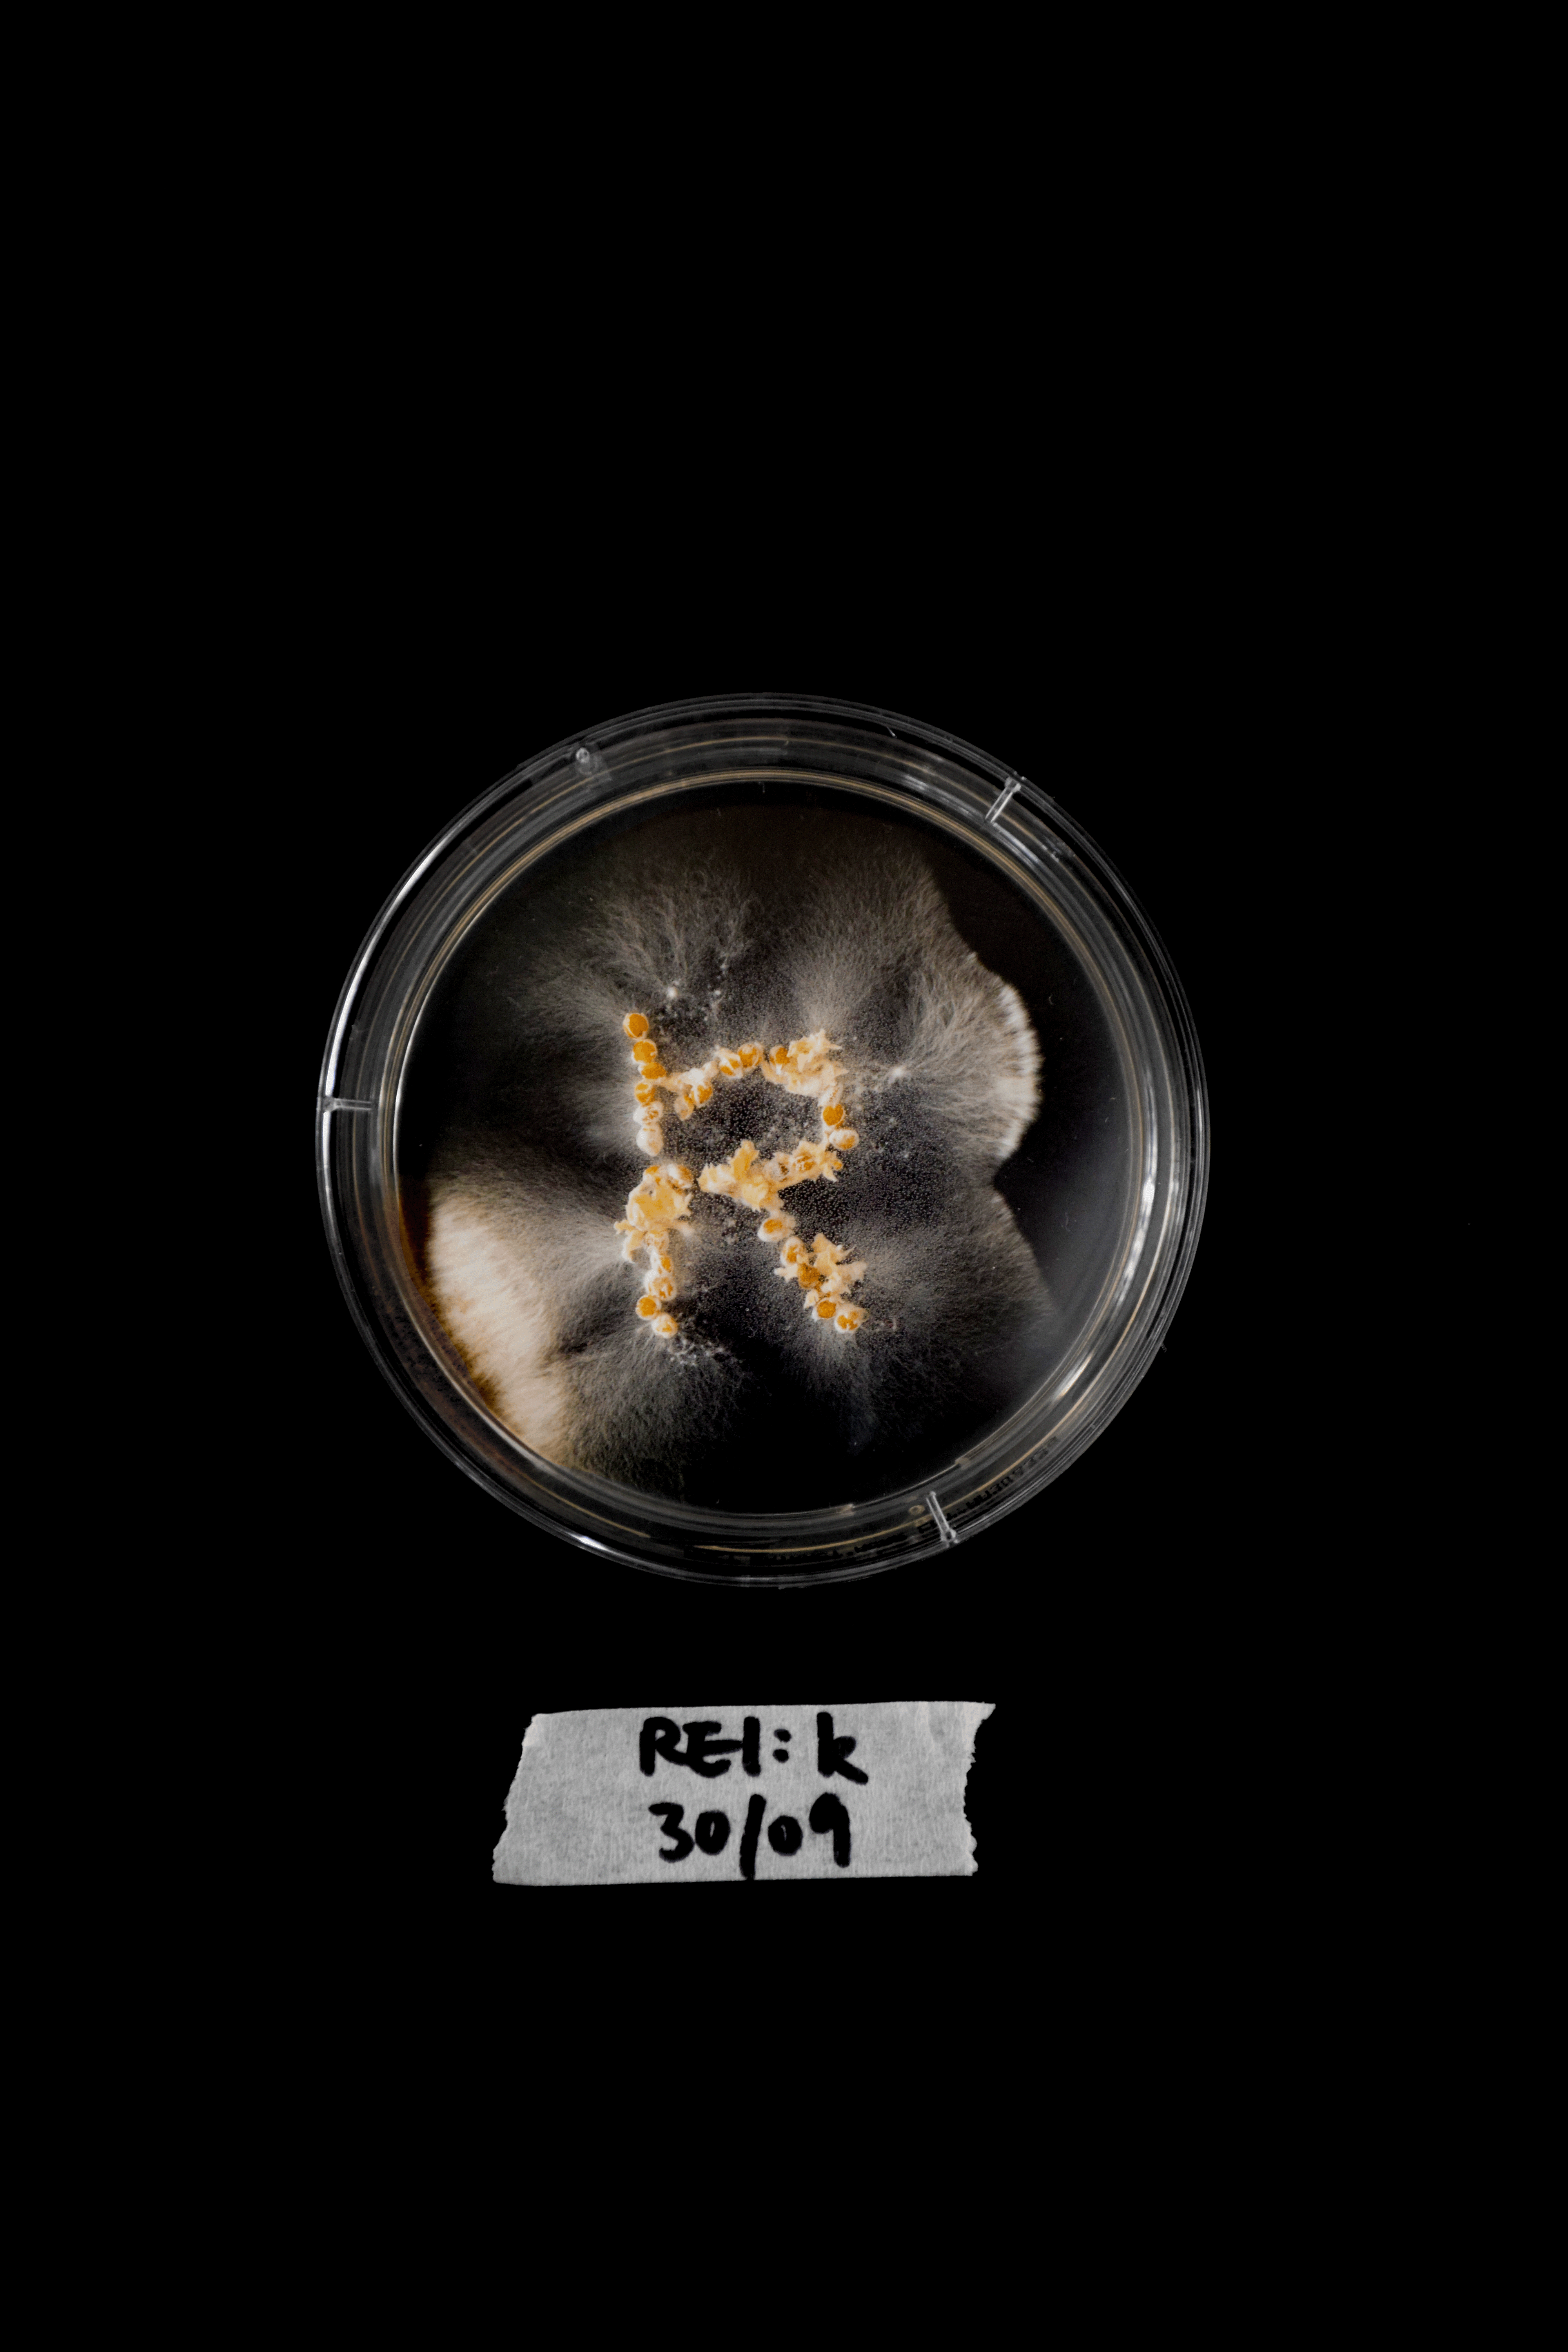

Selected Photographs from Experiment 1A
Alphabet Archive (1A)
Uppercase letters on DAY 1 and DAY 7 respectively
(A)

(B)


(C)

(D)


(E)

(F)


(G)


(H)


(I)

(J)


(K)


(L)


(M)


(N)


(O)


(P)


(Q)

(R)


(S)


(T)


(U)


(V)


(W)


(X)


(Y)

(Z)

Lowercase Letters on DAY 1 and DAY 7 respectively
(a)


(e)


(f)

(g)

(h)

(k)

(m)


(q)


(t)

